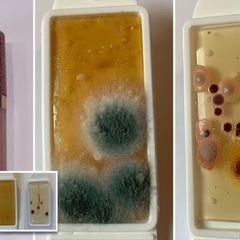

Police News Review at 8 p.m. EST Daily
Current Police News: https://www.inoreader.com/stream/user/1006407045/tag/Police%20News%20Review/view/html?cs=m&sb=y
The News And Times - https://thenewsandtimes.blogspot.com/
Current Selected Articles: https://www.inoreader.com/stream/user/1006407045/tag/user-favorites/view/html
All Current Articles: https://www.inoreader.com/stream/user/1006407045/tag/all-articles/view/html |
| Mother of Xavier Hill sues Virginia State Police for over $60 Million - WWBT |
| Mother of Xavier Hill sues Virginia State Police for over $60 Million WWBT |
 "police" - Google News 4m "police" - Google News 4m |
| Court filings: Man called police to say he would kill wife at daycare job - WSFA |
| Court filings: Man called police to say he would kill wife at daycare job WSFA |
 "police" - Google News 4m "police" - Google News 4m |
| Phoenix police issue statewide alert in search of man suspected of shooting, injuring... |
| Phoenix police issue statewide alert in search of man suspected of shooting, injuring officer The Arizona... |
 "police" - Google News 4m "police" - Google News 4m |
| As Final COVID-19 Vaccine Deadline Passes, At Least 1500 Chicago Police Officers... |
| As Final COVID-19 Vaccine Deadline Passes, At Least 1500 Chicago Police Officers Won't Have to Get Vaccinated:... |
 "police" - Google News 4m "police" - Google News 4m |
| Police find woman dead in St. George home; boyfriend allegedly admitted to crime... |
| Police find woman dead in St. George home; boyfriend allegedly admitted to crime KUTV 2News |
 "police" - Google News 4m "police" - Google News 4m |
| Farmerville Police and Monroe Police recover vehicle from Lake D'Arbonne, driver... |
| Farmerville Police and Monroe Police recover vehicle from Lake D'Arbonne, driver taken to medical facility KTVE... |
 "police" - Google News 4m "police" - Google News 4m |
| Orlando police make arrest in shooting that injured 2 near Coytown - WKMG News 6... |
| Orlando police make arrest in shooting that injured 2 near Coytown WKMG News 6 & ClickOrlando |
 "police" - Google News 4m "police" - Google News 4m |
| KC police bust scheme targeting storage units, find $100k worth of items - WDAF FOX4... |
| KC police bust scheme targeting storage units, find $100k worth of items WDAF FOX4 Kansas City |
 "police" - Google News 4m "police" - Google News 4m |
| City of Boston accepting applications for Police Commissioner - Boston.gov |
| City of Boston accepting applications for Police Commissioner Boston.gov |
 "police" - Google News 4m "police" - Google News 4m |
| London police chided again for corruption, crime links - Reuters |
| London police chided again for corruption, crime links Reuters |
 "police" - Google News 4m "police" - Google News 4m |
| Police: Loaded pistol found in 14-year-old's backpack at Columbus middle school -... |
| Police: Loaded pistol found in 14-year-old's backpack at Columbus middle school 10TV |
 "police" - Google News 34m "police" - Google News 34m |
| Guilderland Police seek help in Sunday Crossgates Mall shooting case; Looking to... |
| Guilderland Police seek help in Sunday Crossgates Mall shooting case; Looking to ID members of two groups... |
 "police" - Google News 34m "police" - Google News 34m |
| Increased police spending leads to more misdemeanor arrests. - Slate |
| Increased police spending leads to more misdemeanor arrests. Slate |
 "police" - Google News 34m "police" - Google News 34m |
| Coachella 2022 security: Police, security prepare as experts anticipate high-energy... |
| Coachella 2022 security: Police, security prepare as experts anticipate high-energy crowd post-COVID Desert... |
 "police" - Google News 34m "police" - Google News 34m |
| One dead, one injured after shooting in Rocky Mount - WSLS 10 |
| One dead, one injured after shooting in Rocky Mount WSLS 10 |
 "police" - Google News 34m "police" - Google News 34m |
| Fentanyl found at Redding apartment as police investigated neighbor complaints -... |
| Fentanyl found at Redding apartment as police investigated neighbor complaints KRCR |
 "police" - Google News 34m "police" - Google News 34m |
| Madison Police searcing for alleged food thieves - WAFF |
| Madison Police searcing for alleged food thieves WAFF |
 "police" - Google News 34m "police" - Google News 34m |
| Rome Police: Man threatened girlfriend with knife over $40 dispute - Rome Sentinel |
| Rome Police: Man threatened girlfriend with knife over $40 dispute Rome Sentinel |
 "police" - Google News 34m "police" - Google News 34m |
| Police seek help to identify man found dead in Dallas creek - FOX 4 News Dallas-Fort... |
| Police seek help to identify man found dead in Dallas creek FOX 4 News Dallas-Fort Worth |
 "police" - Google News 34m "police" - Google News 34m |
| Police: High-speed chase out of SC ends with rollover crash in Cleveland County -... |
| Police: High-speed chase out of SC ends with rollover crash in Cleveland County WSOC Charlotte |
 "police" - Google News 34m "police" - Google News 34m |
| Virginia State Police issues warning about gift card, money phone scams - WRIC ABC... |
| Virginia State Police issues warning about gift card, money phone scams WRIC ABC 8News |
 "police" - Google News 34m "police" - Google News 34m |
 | Charlie Rose attempts #MeToo comeback 5 years after CBS, PBS firing |
| He posted a 75-minute chat with Warren Buffett on his personal website, writing, "It is his first interview... |
 NY Post: NYPD Blotter 35m NY Post: NYPD Blotter 35m |
 | Johnny Depp fans booted from court for alleged violent threats against Amber Heard |
| A Post reporter witnessed the two women looking frazzled when they were approached by court officers... |
 NY Post: NYPD Blotter 35m NY Post: NYPD Blotter 35m |
 | MTA fails to give info on security camera woes in wake of Brooklyn subway shooting |
| The MTA refused to provide an accounting of NYC's subway surveillance system, days after malfunctioning... |
 NY Post: NYPD Blotter 35m NY Post: NYPD Blotter 35m |
 | The contradictory CDC's Title 42 revocation is pure politics |
| It doesn't make sense for the Centers for Disease Control and Prevention to extent its mask mandate on... |
 NY Post: NYPD Blotter 35m NY Post: NYPD Blotter 35m |
 | Kim Jong Un gives North Korea's most famous newscaster a luxury home |
| The anchor became the topic of official North Korean media herself Thursday after leader Kim Jong Un... |
 NY Post: NYPD Blotter 35m NY Post: NYPD Blotter 35m |
 | Former BYU walk-on running back Tyler Allgeier on cusp of NFL future |
| A one-time walk-on, Tyler Allgeier has gone from an afterthought to a projected mid-round 2022 NFL Draft... |
 NY Post: NYPD Blotter 35m NY Post: NYPD Blotter 35m |
 | 'Better Call Saul' is back for its final season: Here's what you need to know |
| It's been two years since "Better Call Saul" aired a new episode -- so you would be well-advised to rewatch... |
 NY Post: NYPD Blotter 35m NY Post: NYPD Blotter 35m |
 | Kyrie Irving's playoff performance will show Nets whether he's worth the trouble |
| Over the next two weeks or two months, Kyrie Irving will either prove he can lead a championship-level... |
 NY Post: NYPD Blotter 35m NY Post: NYPD Blotter 35m |
 | Thandiwe Newton 'heading to rehab' amid divorce, 'Magic Mike' exit |
| Multiple sources say Newton has been battling emotional and family problems after separating from her... |
 NY Post: NYPD Blotter 35m NY Post: NYPD Blotter 35m |
 | Teen stabbed by NYC store owner over shoplifting: police |
| A 16-year-old was stabbed in Lower Manhattan Thursday after a store owner chased him down because the... |
 NY Post: NYPD Blotter 35m NY Post: NYPD Blotter 35m |
 | You can use milk, vodka or soda to grow your plants and kill weeds |
| Chris Bonnett, founder of Gardening Express, said: "People might be surprised to hear that a lot of household... |
 NY Post: NYPD Blotter 35m NY Post: NYPD Blotter 35m |
 | Border Patrol agent 'whip' probe done, produced 500-page report: union |
| The Biden administration has compiled a 500-page report on the probe into Border Patrol agents accused... |
 NY Post: NYPD Blotter 35m NY Post: NYPD Blotter 35m |
 | Akon pays $850K to ex-biz partner in ongoing suit |
| Akon has paid $850,000 to his ex-business partner to settle part of an ongoing lawsuit against the rapper. |
 NY Post: NYPD Blotter 35m NY Post: NYPD Blotter 35m |
 | NYC's rent-stabilized apartments could see lease hikes by as much as 9 percent |
| Roughly one million apartments in the Big Apple have their rent increases set by the nine-member Rent... |
 NY Post: NYPD Blotter 35m NY Post: NYPD Blotter 35m |
 | 'Censorship is free speech' is the establishment's Orwellian line on Elon Musk's... |
| An example of the establishment's aspirations to control debate appeared in a column by former Clinton... |
 NY Post: NYPD Blotter 35m NY Post: NYPD Blotter 35m |
 | K'Andre Miller's Rangers rise has been indispensable |
| K'Andre Miller's dramatic ascension in his second year of professional hockey has perhaps represented... |
 NY Post: NYPD Blotter 35m NY Post: NYPD Blotter 35m |
 | Snobby NYC restaurants too good for garlic: 'It's Italian-American, not Italian' |
| The city's swankiest Italian spots are cutting down on garlic — or doing away with it altogether — to... |
 NY Post: NYPD Blotter 35m NY Post: NYPD Blotter 35m |
 | Hollywood Democratic donor Ed Buck sentenced to 30 years for meth ODs |
| Democratic megadonor Ed Buck was sentenced to 30 years in prison on Thursday for fatally injecting two... |
 NY Post: NYPD Blotter 35m NY Post: NYPD Blotter 35m |
 | Baltimore County Officers Shoot Person After Police Car Rammed During Arrest Attempt... |
| Baltimore County Officers Shoot Person After Police Car Rammed During Arrest Attempt In Dundalk, Police... |
 "police" - Google News 1h "police" - Google News 1h |
| City of Miami Police Department's parking garage shut down over building safety concerns... |
| City of Miami Police Department's parking garage shut down over building safety concerns WPLG Local... |
 "police" - Google News 1h "police" - Google News 1h |
| Police: Caustic liquid thrown on man's face, suspect on the loose - Action News Now |
| Police: Caustic liquid thrown on man's face, suspect on the loose Action News Now |
 "police" - Google News 1h "police" - Google News 1h |
 | Plainville Police Share Resources During Sexual Assault Awareness Month - John Guilfoil... |
| Plainville Police Share Resources During Sexual Assault Awareness Month John Guilfoil Public Relations... |
 "police" - Google News 1h "police" - Google News 1h |
 | Police say Ohio fugitive stole car in Bedford - Monroe Evening News |
| Police say Ohio fugitive stole car in Bedford Monroe Evening News |
 "police" - Google News 1h "police" - Google News 1h |
 | Family of Eric Logan, man killed by South Bend police officer, files appeal seeking... |
| Family of Eric Logan, man killed by South Bend police officer, files appeal seeking trial South Bend... |
 "police" - Google News 1h "police" - Google News 1h |
| Slain NYPD Officer Phillip Cardillo honored 50 years later - New York Daily News |
| Slain NYPD Officer Phillip Cardillo honored 50 years later New York Daily News |
 "NYPD" - Google News 1h "NYPD" - Google News 1h |
| Formal charges filed against woman police say crashed into pond during I-95 pursuit... |
| Formal charges filed against woman police say crashed into pond during I-95 pursuit WJXT News4JAX |
 "police" - Google News 1h "police" - Google News 1h |
| Virginia outlaws police from setting traffic ticket quotas - CBS 6 News Richmond... |
| Virginia outlaws police from setting traffic ticket quotas CBS 6 News Richmond WTVR |
 "police" - Google News 1h "police" - Google News 1h |
| Police Reports, April 14, 2022 - Reading Eagle |
| Police Reports, April 14, 2022 Reading Eagle |
 "police" - Google News 1h "police" - Google News 1h |
| Champaign Police Announce "Last Ride" Procession for K-9 Cash - City of Champaign... |
| Champaign Police Announce "Last Ride" Procession for K-9 Cash City of Champaign IL (.gov) |
 "police" - Google News 1h "police" - Google News 1h |
| Despite subpoena, former State Police leader a no-show at disciplinary hearing tied... |
| Despite subpoena, former State Police leader a no-show at disciplinary hearing tied to Ronald Greene... |
 "police" - Google News 1h "police" - Google News 1h |
| Citizens Blast NYPD For 'Harassing' Residents in Wake of Subway Shooting - Newsweek |
| Citizens Blast NYPD For 'Harassing' Residents in Wake of Subway Shooting Newsweek |
 "NYPD" - Google News 1h "NYPD" - Google News 1h |
| Police shooting at Larimer County landfill injures assault suspect; landfill closed... |
| Police shooting at Larimer County landfill injures assault suspect; landfill closed Coloradoan |
 "police" - Google News 2h "police" - Google News 2h |
| 77-year-old Va. man injured in three-vehicle crash dies, police say - The Washington... |
| 77-year-old Va. man injured in three-vehicle crash dies, police say The Washington Post |
 "police" - Google News 2h "police" - Google News 2h |
| Human skull, remains discovered outside Roanoke County home - WSLS 10 |
| Human skull, remains discovered outside Roanoke County home WSLS 10 |
 "police" - Google News 2h "police" - Google News 2h |
| 'Unfit to serve' Knoxville Police officer pleads guilty to lying on arrest report,... |
| 'Unfit to serve' Knoxville Police officer pleads guilty to lying on arrest report, resigns WATE 6 On... |
 "police" - Google News 2h "police" - Google News 2h |
| Police report details alleged murder of St. George woman at hands of boyfriend -... |
| Police report details alleged murder of St. George woman at hands of boyfriend St George News |
 "police" - Google News 2h "police" - Google News 2h |
| Person shot, injured outside rapper DaBaby's mansion in Troutman, police say - WGHP... |
| Person shot, injured outside rapper DaBaby's mansion in Troutman, police say WGHP FOX8 Greensboro |
 "police" - Google News 2h "police" - Google News 2h |
| 2 people hurt after someone shot into a vehicle in Orlando, police say - FOX 35 Orlando |
| 2 people hurt after someone shot into a vehicle in Orlando, police say FOX 35 Orlando |
 "police" - Google News 2h "police" - Google News 2h |
| Man fatally shot by police in Bristol fired multiple shots, pointed gun at officer:... |
| Man fatally shot by police in Bristol fired multiple shots, pointed gun at officer: TBI WCYB |
 "police" - Google News 2h "police" - Google News 2h |
 | Letters to the Editor — April 15, 2022 |
| New York Post readers sound off about the resignation of Lt. Gov. Brian Benjamin after being indicted... |
 NY Post: NYPD Blotter 2h NY Post: NYPD Blotter 2h |
 | Harry and Meghan finally reunite with Queen, Prince Charles amid family feud |
| The Sussexes have seen the Queen -- and Prince Charles -- together for the first time in more than 2... |
 NY Post: NYPD Blotter 2h NY Post: NYPD Blotter 2h |
 | Kyler Murray and the Cardinals appear to have more drama |
| The showdown between Kyler Murray and the Cardinals has continued with the news that they have not yet... |
 NY Post: NYPD Blotter 2h NY Post: NYPD Blotter 2h |
 | Stream It Or Skip It: 'The Garcias' On HBO Max, A Next-Generation Follow-Up To The... |
| All of the original stars from the 2000-03 Nickelodeon sitcom return, but now they have families of their... |
 NY Post: NYPD Blotter 2h NY Post: NYPD Blotter 2h |
 | Council Speaker Adrienne Adams challenges Mayor Adams' link of BLM protests to violent... |
| The City Council Speaker challenged Mayor Eric Adam's assertion that police brutality protests are somehow... |
 NY Post: NYPD Blotter 2h NY Post: NYPD Blotter 2h |
 | Inside Gilbert Gottfried's emotional and comedy-filled funeral |
| "What a mitzvah. What a mission in life, what a purpose to have in this world. And he wasn't just regular... |
 NY Post: NYPD Blotter 2h NY Post: NYPD Blotter 2h |
 | Man's 'stomach pains' turns out to be headphone wire lodged in his bladder |
| An Indonesian man's stomach pains turned out to be caused by a 31-inch headphone wire lodged in his bladder... |
 NY Post: NYPD Blotter 2h NY Post: NYPD Blotter 2h |
 | 'Up In The Blue Seats' Podcast Episode 84: Chris Kreider Reaches 50 Goals, Rangers... |
| The Blueshirts have clinched a playoff spot and are still in the running to win the Metropolitan division. |
 NY Post: NYPD Blotter 2h NY Post: NYPD Blotter 2h |
 | The sweet secret weapon behind Britney Spears' pregnancy reveal |
| Britney Spears' pregnancy announcement featured a photo from an Ohio-based part-time stock photographer... |
 NY Post: NYPD Blotter 2h NY Post: NYPD Blotter 2h |
 | Gilbert Gottfried's widow: His jokes were dirty, but his heart was pure |
| The comic's widow Dara Kravitz had friends and family laughing — and crying — as she paid tribute to... |
 NY Post: NYPD Blotter 2h NY Post: NYPD Blotter 2h |
 | Biden vows billions for 'Build Back Better World' with US version blocked |
| "We're going to export billions of dollars worth of product for the rest of the world," President Joe... |
 NY Post: NYPD Blotter 2h NY Post: NYPD Blotter 2h |
 | Windy City cottage that survived the Great Chicago Fire asks $2.4M |
| Located at 2121 N. Hudson Ave., this Italianate cottage was one of three North Side homes to survive... |
 NY Post: NYPD Blotter 2h NY Post: NYPD Blotter 2h |
 | Amber Heard verbally abused me, paid 'very poorly,' ex-assistant says |
| Kate James worked for Amber Heard from 2012 and 2015, and gave biting testimony via deposition played... |
 NY Post: NYPD Blotter 2h NY Post: NYPD Blotter 2h |
 | Stream It Or Skip It: 'Killing It' On Peacock, Where Craig Robinson Achieves The... |
| Claudia O'Doherty and Rell Battle co-star with Robinson in a series produced by Brooklyn Nine-Nine's Dan... |
 NY Post: NYPD Blotter 2h NY Post: NYPD Blotter 2h |
 | BetMGM Bonus Code: Epic bonus for a super sports schedule |
| BetMGM's new customer offer allows you to make your first sports bet risk free, ahead of a spectacular... |
 NY Post: NYPD Blotter 2h NY Post: NYPD Blotter 2h |
 | Devils vs. Avalanche odds, predictions: Pros betting NHL underdogs |
| Pro bettors are all over these NHL underdogs as the season nears a close. |
 NY Post: NYPD Blotter 2h NY Post: NYPD Blotter 2h |
 | Paige Spiranac opens up on crying press conference: Blackmail, threats and trolling |
| Paige Spiranac fired back Thursday at a Twitter troll over a hurtful comment that called attention to... |
 NY Post: NYPD Blotter 2h NY Post: NYPD Blotter 2h |
 | Elon Musk could have competition: Thoma Bravo considers Twitter bid |
| Private equity giant Thoma Bravo is working on a possible bid for Twitter, a source close to the situation... |
 NY Post: NYPD Blotter 2h NY Post: NYPD Blotter 2h |
 | Actress Garcelle Beauvais reveals Michael Jordan romance regrets |
| Beauvais admits in the book that she ended things with Jordan after he invited her on a romantic trip... |
 NY Post: NYPD Blotter 2h NY Post: NYPD Blotter 2h |
| Staten Island man loses $1.7 million in shocking computer virus scam, says NYPD -... |
| Staten Island man loses $1.7 million in shocking computer virus scam, says NYPD SILive.com |
 "NYPD" - Google News 2h "NYPD" - Google News 2h |
| NYC baby's death after Bronx window toss was homicide, say cops - New York Daily... |
| NYC baby's death after Bronx window toss was homicide, say cops New York Daily News |
 "NYPD" - Google News 2h "NYPD" - Google News 2h |
| Suspicious characters pose burning question: Moreland Hills Police Blotter - cleveland.com |
| Suspicious characters pose burning question: Moreland Hills Police Blotter cleveland.com |
 "police" - Google News 2h "police" - Google News 2h |
| City of Boston Provides Update on Police Commissioner Search Process - Boston.gov |
| City of Boston Provides Update on Police Commissioner Search Process Boston.gov |
 "police" - Google News 2h "police" - Google News 2h |
| Village of Phoenix Police searching for two women who destroyed Henley Park - CNYcentral.com |
| Village of Phoenix Police searching for two women who destroyed Henley Park CNYcentral.com |
 "police" - Google News 2h "police" - Google News 2h |
| Man arrested in Natchez for kidnapping; Victim mouths 'help me' to police officer... |
| Man arrested in Natchez for kidnapping; Victim mouths 'help me' to police officer from inside his vehicle... |
 "police" - Google News 2h "police" - Google News 2h |
| London police seize Club Penguin clone site, three suspects arrested - Polygon |
| London police seize Club Penguin clone site, three suspects arrested Polygon |
 "police" - Google News 2h "police" - Google News 2h |
| Maplewood police release body cam footage of officers who detained and handcuffed... |
| Maplewood police release body cam footage of officers who detained and handcuffed 4 kids St. Paul Pioneer... |
 "police" - Google News 2h "police" - Google News 2h |
| Officer finds steamy situation in park: Olmsted Falls Police Blotter - cleveland.com |
| Officer finds steamy situation in park: Olmsted Falls Police Blotter cleveland.com |
 "police" - Google News 3h "police" - Google News 3h |
| Vinton Police ask for help finding missing teen - WDBJ |
| Vinton Police ask for help finding missing teen WDBJ |
 "police" - Google News 3h "police" - Google News 3h |
| Fort Collins Police Services becomes first to bring the Vitals™ App to Colorado ||... |
| Fort Collins Police Services becomes first to bring the Vitals™ App to Colorado || News FCGOV.com |
 "police" - Google News 3h "police" - Google News 3h |
| Fort Myers police body cameras getting an upgrade - Wink News |
| Fort Myers police body cameras getting an upgrade Wink News |
 "police" - Google News 3h "police" - Google News 3h |
| Several Cars Vandalized at Schaumburg Dealership, Police Estimate $50,000 in Damages... |
| Several Cars Vandalized at Schaumburg Dealership, Police Estimate $50,000 in Damages NBC Chicago |
 "police" - Google News 3h "police" - Google News 3h |
| Millcreek Police Look to Identify Woman in At Home Theft Investigation - erienewsnow.com |
| Millcreek Police Look to Identify Woman in At Home Theft Investigation erienewsnow.com |
 "police" - Google News 3h "police" - Google News 3h |
| Police: Four people try to enter gun store through vents in Grove City - NBC4 WCMH-TV |
| Police: Four people try to enter gun store through vents in Grove City NBC4 WCMH-TV |
 "police" - Google News 3h "police" - Google News 3h |
| Knoxville police officer pleads guilty to tampering with records, then resigns -... |
| Knoxville police officer pleads guilty to tampering with records, then resigns Knoxville News Sentinel |
 "police" - Google News 3h "police" - Google News 3h |
| Police: Man failed to call 911 during suspected fentanyl overdose at east Austin... |
| Police: Man failed to call 911 during suspected fentanyl overdose at east Austin grill KXAN.com |
 "police" - Google News 3h "police" - Google News 3h |
| Man arrested after police pursuit and armed carjacking in Newtown - Eyewitness News... |
| Man arrested after police pursuit and armed carjacking in Newtown Eyewitness News 3 |
 "police" - Google News 3h "police" - Google News 3h |
| Motorcyclist who led police on chase barricaded inside Brazoria County home, HPD... |
| Motorcyclist who led police on chase barricaded inside Brazoria County home, HPD says KPRC Click2Houston |
 "police" - Google News 3h "police" - Google News 3h |
| GRAPHIC: Police release bodycam video of deadly officer-involved shooting - FOX19 |
| GRAPHIC: Police release bodycam video of deadly officer-involved shooting FOX19 |
 "police" - Google News 3h "police" - Google News 3h |
| Milwaukee Police are searching for critically missing 11-year-old Patrice Harris,... |
| Milwaukee Police are searching for critically missing 11-year-old Patrice Harris, last seen near Borchert... |
 "police" - Google News 3h "police" - Google News 3h |
| Port Huron Police to hold Autism Acceptance Day - The Times Herald |
| Port Huron Police to hold Autism Acceptance Day The Times Herald |
 "police" - Google News 3h "police" - Google News 3h |
| Marion Police say bank robbery suspect was killed by police after a California heist... |
| Marion Police say bank robbery suspect was killed by police after a California heist WSIL TV |
 "police" - Google News 3h "police" - Google News 3h |
| Suspect in stolen police truck crashes in South Bay after high-speed pursuit - FOX... |
| Suspect in stolen police truck crashes in South Bay after high-speed pursuit FOX 5 San Diego |
 "police" - Google News 3h "police" - Google News 3h |
 | Camila Cabello channels Britney Spears in denim-on-denim outfit |
| The former Fifth Harmony member wore jeans paired with a denim corset, gloves and multiple jackets, including... |
 NY Post: NYPD Blotter 3h NY Post: NYPD Blotter 3h |
 | The Sony 65-Inch X80J Smart Google TV Is $100 Off Today |
| This LED 4K TV comes with Google Smart TV features for all your streaming needs. |
 NY Post: NYPD Blotter 3h NY Post: NYPD Blotter 3h |
 | Ex-Trump aide Stephen Miller appears before House Jan. 6 riot panel |
| Former White House adviser to Donald Trump Stephen Miller appeared before the House select committee... |
 NY Post: NYPD Blotter 3h NY Post: NYPD Blotter 3h |
 | Oilers vs. Predators odds, prediction: Edmonton looks to keep rolling |
| The red-hot Oilers take on the Predators. Action Network's Michael Leboff has the betting breakdown for... |
 NY Post: NYPD Blotter 3h NY Post: NYPD Blotter 3h |
 | Angels vs. Rangers prediction: Bet on Shohei Ohtani |
| Bet on Shohei Ohtani and the Angels to beat the Rangers on Thursday night in Texas. |
 NY Post: NYPD Blotter 3h NY Post: NYPD Blotter 3h |
 | Many Jews are fed up with Christians hosting Passover seders of their own |
| For the last few Passover holidays, Talia Liben Yarmush has heard about Christians holding seders, the... |
 NY Post: NYPD Blotter 3h NY Post: NYPD Blotter 3h |
 | 11 best online vintage clothing and thrift stores to shop in 2022 |
| There's nothing like discovering a hidden gem. |
 NY Post: NYPD Blotter 3h NY Post: NYPD Blotter 3h |
 | How the Notre-Dame Cathedral has been repaired — 3 years after horrifying fire |
| Three years after a devastating fire ripped through the Notre Dame Cathedral, nearly a billion dollars... |
 NY Post: NYPD Blotter 3h NY Post: NYPD Blotter 3h |
 | Illinois man allegedly shot neighbor's dog in front of 10-year-old |
| John Fazzini, 61, was arrested in the March 10 shooting of an 8-year-old German shepherd mix named Jameson... |
 NY Post: NYPD Blotter 3h NY Post: NYPD Blotter 3h |
 | North Korean hacker group Lazarus linked to $615M cryptocurrency theft |
| The US government has linked North Korean hackers to the theft of $615 million worth of cryptocurrency... |
 NY Post: NYPD Blotter 3h NY Post: NYPD Blotter 3h |
 | Thief swipes running car with baby on board in Queens: NYPD |
| A thief swiped a car with a baby on board in Queens on Thursday morning -- after a babysitter left the... |
 NY Post: NYPD Blotter 3h NY Post: NYPD Blotter 3h |
 | 'Smoking Roach' snuffs out 'Pizza Rat' as NYC's grossest vermin |
| A video of the tiny tobacco toker is currently blowing up on Instagram as urban wildlife enthusiasts... |
 NY Post: NYPD Blotter 3h NY Post: NYPD Blotter 3h |
 | Tom Brady wants a favor from Elon Musk if he buys Twitter |
| Tom Brady is still haunted by an old photo and is asking Elon Musk to do something about it if Musk buys... |
 NY Post: NYPD Blotter 3h NY Post: NYPD Blotter 3h |
 | Your Coachella personality and style based on your zodiac sign |
| Coachella is here. Find out how your zodiac sign will rock the festival! |
 NY Post: NYPD Blotter 3h NY Post: NYPD Blotter 3h |
 | MTV VJ Karen Duffy: I went 'out with a bang' before chronic pain diagnoses |
| While discussing her new book, "Duff," now 60, recalled going "out with a bang" with George Clooney the... |
 NY Post: NYPD Blotter 3h NY Post: NYPD Blotter 3h |
 | Death of the 'chill girl' myth: Why women no longer hide being 'bats–t' |
| Eli Rallo hs declared the once trendy "chill girl" persona – a girl who's just "one of the boys" and... |
 NY Post: NYPD Blotter 3h NY Post: NYPD Blotter 3h |
 | Flippin' awesome kid does wheelchair backflip |
| This was wheel-y cool. A 12-year-old wheelchair motocrosser pulled off a badass backflip at a skatepark... |
 NY Post: NYPD Blotter 3h NY Post: NYPD Blotter 3h |
 | The 15 best swimsuit cover ups of 2022, according to Amazon reviews |
| It's time to get ready for warm weather. |
 NY Post: NYPD Blotter 3h NY Post: NYPD Blotter 3h |
| Police: Homestead mother arrested after attempting to strangle one of her children... |
| Police: Homestead mother arrested after attempting to strangle one of her children WPLG Local 10 |
 "police" - Google News 4h "police" - Google News 4h |
| Police arrest man in Springfield wanted for armed carjacking in Wisconsin - KY3 |
| Police arrest man in Springfield wanted for armed carjacking in Wisconsin KY3 |
 "police" - Google News 4h "police" - Google News 4h |
| Video: 3-state police pursuit ends with PIT maneuver - Police News |
| Video: 3-state police pursuit ends with PIT maneuver Police News |
 "police" - Google News 4h "police" - Google News 4h |
| Idaho Falls police seeking information about burglary at local home - East Idaho... |
| Idaho Falls police seeking information about burglary at local home East Idaho News |
 "police" - Google News 4h "police" - Google News 4h |
| Kingston Police Department needs full-time clerk to handle reform-related workload,... |
| Kingston Police Department needs full-time clerk to handle reform-related workload, chief says The Daily... |
 "police" - Google News 4h "police" - Google News 4h |
| Kansas City police investigating 'enormous amount' of stolen goods from storage units... |
| Kansas City police investigating 'enormous amount' of stolen goods from storage units KCTV 5 |
 "police" - Google News 4h "police" - Google News 4h |
| Police identify student dead in Northeast Middle School stabbing as 14-year-old boy... |
| Police identify student dead in Northeast Middle School stabbing as 14-year-old boy WIBW |
 "police" - Google News 4h "police" - Google News 4h |
| Teen arrested in attack on Sikh man visiting from India: NYPD - Spectrum News NY1 |
| Teen arrested in attack on Sikh man visiting from India: NYPD Spectrum News NY1 |
 "NYPD" - Google News 4h "NYPD" - Google News 4h |
| Jackson police arrest 2 while investigating shots fired complaint - MLive.com |
| Jackson police arrest 2 while investigating shots fired complaint MLive.com |
 "police" - Google News 4h "police" - Google News 4h |
| Police investigating drive-by shooting in Idaho Falls - East Idaho News |
| Police investigating drive-by shooting in Idaho Falls East Idaho News |
 "police" - Google News 4h "police" - Google News 4h |
| Cambridge police investigate sexual assault reported near Porter Square shopping... |
| Cambridge police investigate sexual assault reported near Porter Square shopping center Boston.com |
 "police" - Google News 4h "police" - Google News 4h |
| Jeannette native killed in Phoenix; police charge husband with homicide - TribLIVE |
| Jeannette native killed in Phoenix; police charge husband with homicide TribLIVE |
 "police" - Google News 4h "police" - Google News 4h |
| Police, family release names of teens killed in Genesee house fire - WETM - MyTwinTiers.com |
| Police, family release names of teens killed in Genesee house fire WETM - MyTwinTiers.com |
 "police" - Google News 4h "police" - Google News 4h |
| Police: Officer Shoots Man Who Pointed Gun During Pursuit - U.S. News & World Report |
| Police: Officer Shoots Man Who Pointed Gun During Pursuit U.S. News & World Report |
 "police" - Google News 5h "police" - Google News 5h |
| Manhunt continues for suspect in Phoenix officer-involved shooting. - Arizona's Family |
| Manhunt continues for suspect in Phoenix officer-involved shooting. Arizona's Family |
 "police" - Google News 5h "police" - Google News 5h |
| Sources: Police on scene of barricade situation in Kapahulu - Hawaii News Now |
| Sources: Police on scene of barricade situation in Kapahulu Hawaii News Now |
 "police" - Google News 5h "police" - Google News 5h |
| Police: Over 50 vehicles broken into Watertown this month - Dakota News Now |
| Police: Over 50 vehicles broken into Watertown this month Dakota News Now |
 "police" - Google News 5h "police" - Google News 5h |
| NJ attorney general: Off-duty cops can use legal weed, per marijuana legalization... |
| NJ attorney general: Off-duty cops can use legal weed, per marijuana legalization laws Asbury Park Press |
 "police" - Google News 5h "police" - Google News 5h |
| Rogers police investigating homicide after girl found shot in head - KNWA |
| Rogers police investigating homicide after girl found shot in head KNWA |
 "police" - Google News 5h "police" - Google News 5h |
| Boy, 2, Dies After Dad Accidentally Runs Over Him While Parking: 'Tragic Situation,'... |
| Boy, 2, Dies After Dad Accidentally Runs Over Him While Parking: 'Tragic Situation,' Police Say PEOPLE |
 "police" - Google News 5h "police" - Google News 5h |
| Maryland State Police Identify Body Found On I-95 - maryland.gov |
| Maryland State Police Identify Body Found On I-95 maryland.gov |
 "police" - Google News 5h "police" - Google News 5h |
| Police Log: April 14, 2022 - WBIW.com |
| Police Log: April 14, 2022 WBIW.com |
 "police" - Google News 5h "police" - Google News 5h |
| Deputy police chief sentenced after second DUI led to resignation - Dayton Daily... |
| Deputy police chief sentenced after second DUI led to resignation Dayton Daily News |
 "police" - Google News 5h "police" - Google News 5h |
| Suspect arrested after leading authorities on chase in stolen El Cajon Police truck... |
| Suspect arrested after leading authorities on chase in stolen El Cajon Police truck CBS News 8 |
 "police" - Google News 5h "police" - Google News 5h |
 | Joey Votto claims Joe Burrow mocked him for being too 'old for TikTok' |
| Will Bengals quarterback Joe Burrow influence Joey Votto to retire from TikTok? |
 NY Post: NYPD Blotter 5h NY Post: NYPD Blotter 5h |
 | Alleged shooter Frank James' past arrests include threatening former boss |
| The alleged gunman in the Brooklyn subway shooting was arrested in New Jersey over two decades ago for... |
 NY Post: NYPD Blotter 5h NY Post: NYPD Blotter 5h |
 | Steve Bannon to be called as witness in 'We Build the Wall' fraud case |
| In legal papers filed Thursday, Timothy Shea said "intends to call Mr. Bannon as a witness" for the defense... |
 NY Post: NYPD Blotter 5h NY Post: NYPD Blotter 5h |
 | Media downplays accused Brooklyn subway shooter Frank James' hatred of whites |
| Though alleged Brooklyn subway shooter Frank James does spew hate about some black people, particularly... |
 NY Post: NYPD Blotter 5h NY Post: NYPD Blotter 5h |
 | Cristian Pache scores little league home run for A's after Rays outfield disaster |
| Cristian Pache hit a ground ball that turned into a Little League home run, one of the strangest plays... |
 NY Post: NYPD Blotter 5h NY Post: NYPD Blotter 5h |
 | 'Jeopardy!' gets new boss after Mike Richards scandal |
| The cast and crew of "Jeopardy!" have a new head honcho to answer to after Mike Richards was fired in... |
 NY Post: NYPD Blotter 5h NY Post: NYPD Blotter 5h |
 | Peloton cuts bike prices – but hikes monthly subscription fees |
| Peloton is raising the monthly fee for its on-demand fitness content in the United States and Canada,... |
 NY Post: NYPD Blotter 5h NY Post: NYPD Blotter 5h |
 | Driver repeatedly runs over woman in horrifying caught-on-camera road rage attack |
| The harrowing footage captured Tuesday by a witness in Elizabeth shows the moment Vincent Jean, 56, drove... |
 NY Post: NYPD Blotter 5h NY Post: NYPD Blotter 5h |
 | Kevin Durant 'not expecting' Ben Simmons to play against Celtics |
| Amid rumors Ben Simmons would make his Nets debut against the Celtics, Steve Nash and Kevin Durant dumped... |
 NY Post: NYPD Blotter 5h NY Post: NYPD Blotter 5h |
 | Can you work out what these mind-blowing iPhone photos really are? |
| Apple has revealed its 10 best 'Shot on iPhone' photos for 2022 – with a big twist. |
 NY Post: NYPD Blotter 5h NY Post: NYPD Blotter 5h |
 | NoMad Hotel tests first luxury condo project in Miami's Wynwood |
| The hotel brand – which operates in London, Los Angeles and Las Vegas, but no longer in its namesake... |
 NY Post: NYPD Blotter 5h NY Post: NYPD Blotter 5h |
 | Julia Haart denies Silvio Scaglia's 'ludicrous' legal allegations |
| "I've never taken a penny that doesn't belong to me, and the beauty of knowing the truth is you know... |
 NY Post: NYPD Blotter 5h NY Post: NYPD Blotter 5h |
 | Actors with Down syndrome to star in Hallmark romance movie |
| The movie, which recently wrapped production, will air later this year. |
 NY Post: NYPD Blotter 5h NY Post: NYPD Blotter 5h |
 | Seahawks re-sign Geno Smith as Baker Mayfield sets sights on Seattle |
| As Baker Mayfield eyes Seattle as a potential landing spot, the Seahawks brought back one of their quarterbacks. |
 NY Post: NYPD Blotter 5h NY Post: NYPD Blotter 5h |
 | Venice seagull problem leads to squirt gun distribution at high-end hotels |
| Reports of food-stealing seagulls in Italy comes just when the world responds to avian flu outbreaks |
 NY Post: NYPD Blotter 5h NY Post: NYPD Blotter 5h |
 | Tinder Festival Mode allows pent-up users to match before events |
| Tinder launched its newest feature allowing singles to match with fellow concert and festival goers weeks... |
 NY Post: NYPD Blotter 5h NY Post: NYPD Blotter 5h |
 | Former Auburn quarterback Jeff Klein dead at 42 |
| Jeff Klein, who played quarterback for Auburn from 1999 to 2001 and was the starting quarterback in his... |
 NY Post: NYPD Blotter 5h NY Post: NYPD Blotter 5h |
 | MTA CEO blames subway shooting camera fail on bad 'internet connection' |
| The top transit boss said the media was wrong to focus on the non-working cameras, which sources close... |
 NY Post: NYPD Blotter 5h NY Post: NYPD Blotter 5h |
 | Inside China's plan to find 'Earth 2.0' with this planet-hunting probe |
| China is working on a plan to locate the first Earth-like planet in deep space. |
 NY Post: NYPD Blotter 5h NY Post: NYPD Blotter 5h |
 | Did The Oscars Slap Cost Thandiwe Newton Her Job On 'Magic Mike' Movie? |
| They didn't save the Last Dance for her |
 NY Post: NYPD Blotter 5h NY Post: NYPD Blotter 5h |
| Youngstown police collect 50 shell casings at two shooting scenes - WKBN.com |
| Youngstown police collect 50 shell casings at two shooting scenes WKBN.com |
 "police" - Google News 5h "police" - Google News 5h |
| Person of interest in 2 St. Petersburg shootings is in custody, police say - Tampa... |
| Person of interest in 2 St. Petersburg shootings is in custody, police say Tampa Bay Times |
 "police" - Google News 5h "police" - Google News 5h |
| Police: Driver hit pedestrian with car after multiple attempts - Dakota News Now |
| Police: Driver hit pedestrian with car after multiple attempts Dakota News Now |
 "police" - Google News 5h "police" - Google News 5h |
| Police: Man arrested in connection to West Broad Street bank robbery - WWBT |
| Police: Man arrested in connection to West Broad Street bank robbery WWBT |
 "police" - Google News 5h "police" - Google News 5h |
| Ala. gov. signs 'Nick Risner Act' in honor of slain police sergeant - Police News |
| Ala. gov. signs 'Nick Risner Act' in honor of slain police sergeant Police News |
 "police" - Google News 5h "police" - Google News 5h |
| Reward being offered for information on allegedly stolen Boston police uniforms -... |
| Reward being offered for information on allegedly stolen Boston police uniforms Boston.com |
 "police" - Google News 5h "police" - Google News 5h |
| Police warn of catalytic converter thefts in Columbia County - NEWS10 ABC |
| Police warn of catalytic converter thefts in Columbia County NEWS10 ABC |
 "police" - Google News 6h "police" - Google News 6h |
| Tampa police arrest accused serial bank robber - FOX 13 Tampa |
| Tampa police arrest accused serial bank robber FOX 13 Tampa |
 "police" - Google News 6h "police" - Google News 6h |
| Proctor police search for missing 79-year-old - Duluth News Tribune |
| Proctor police search for missing 79-year-old Duluth News Tribune |
 "police" - Google News 6h "police" - Google News 6h |
| Man standing on North Side railroad tracks hit by freight train, police say - KSAT... |
| Man standing on North Side railroad tracks hit by freight train, police say KSAT San Antonio |
 "police" - Google News 6h "police" - Google News 6h |
| Woman arrested after police see her smoking meth - WBIW.com |
| Woman arrested after police see her smoking meth WBIW.com |
 "police" - Google News 6h "police" - Google News 6h |
| Pianist continues to play Schubert 'Impromptu', as Russian police break up concert... |
| Pianist continues to play Schubert 'Impromptu', as Russian police break up concert of Ukrainian music Classic... |
 "police" - Google News 6h "police" - Google News 6h |
| Man in critical condition after being shot inside Cleveland office building, police... |
| Man in critical condition after being shot inside Cleveland office building, police say Cleveland 19... |
 "police" - Google News 6h "police" - Google News 6h |
| Justice Department and Springfield officials announce police department consent decree... |
| Justice Department and Springfield officials announce police department consent decree WBUR |
 "police" - Google News 6h "police" - Google News 6h |
| State Police investigating Lafayette officer-involved shooting - KATC News |
| State Police investigating Lafayette officer-involved shooting KATC News |
 "police" - Google News 6h "police" - Google News 6h |
| Parents of detained children want apology from Maplewood Police - MPR News |
| Parents of detained children want apology from Maplewood Police MPR News |
 "police" - Google News 6h "police" - Google News 6h |
 | Suspect sought in teen stabbing at 7 train subway station in Elmhurst: NYPD – QNS.com... |
| Suspect sought in teen stabbing at 7 train subway station in Elmhurst: NYPD – QNS.com QNS.com |
 "NYPD" - Google News 6h "NYPD" - Google News 6h |
 | Video NYPD: Subway suspect Frank James called police on himself - ABC News |
| Video NYPD: Subway suspect Frank James called police on himself ABC News |
 "NYPD" - Google News 6h "NYPD" - Google News 6h |
| Flint police seeking missing teen last seen on April 7 - MLive.com |
| Flint police seeking missing teen last seen on April 7 MLive.com |
 "police" - Google News 6h "police" - Google News 6h |
| Police ask people to stay inside during Christiansburg manhunt - WDBJ |
| Police ask people to stay inside during Christiansburg manhunt WDBJ |
 "police" - Google News 6h "police" - Google News 6h |
| Man dead, hostage safe after 19-hour armed standoff in Guilford, police say; man's... |
| Man dead, hostage safe after 19-hour armed standoff in Guilford, police say; man's gunshot wound appears... |
 "police" - Google News 6h "police" - Google News 6h |
| Lansing Police investigate deadly shooting - WLNS |
| Lansing Police investigate deadly shooting WLNS |
 "police" - Google News 6h "police" - Google News 6h |
| Justice Department and Springfield officials announce police department consent decree... |
| Justice Department and Springfield officials announce police department consent decree Connecticut Public |
 "police" - Google News 6h "police" - Google News 6h |
 | Mobster Whitey Bulger's nephew played role in Hunter Biden's Chinese business ventures:... |
| The namesake nephew of bloodthirsty Boston mobster James "Whitey" Bulger worked closely with Hunter Biden... |
 NY Post: NYPD Blotter 6h NY Post: NYPD Blotter 6h |
 | Wendy Williams is ready for her television and financial comeback |
| The TV personality was overheard telling peers at dinner Wednesday night that she's ready for her comeback... |
 NY Post: NYPD Blotter 6h NY Post: NYPD Blotter 6h |
 | Woman killed by falling tree as storms hit Midwest, South |
| The woman's death occurred Wednesday as part of a multiday severe weather outbreak that caused tornadoes,... |
 NY Post: NYPD Blotter 6h NY Post: NYPD Blotter 6h |
 | NY issuing first licenses for 52 marijuana farmers |
| The cannabis grown by farmers or "cultivators" awarded licenses Thursday will feed the first products... |
 NY Post: NYPD Blotter 6h NY Post: NYPD Blotter 6h |
 | Ex-cop Myles Cosgrove, who fatally shot Breonna Taylor, sues to get his job back |
| Ex-detective Myles Cosgrove claims the Louisville Metro Police Merit Board acted "in violation of due... |
 NY Post: NYPD Blotter 6h NY Post: NYPD Blotter 6h |
 | Accused Brooklyn subway shooter Frank James arraigned, held without bail |
| Federal prosecutors said James was accused of "terrifyingly opened fire" Tuesday on a train car in Sunset... |
 NY Post: NYPD Blotter 6h NY Post: NYPD Blotter 6h |
 | Alexander Volkanovski wants a second belt now after UFC 273 dominance |
| Moments after having his hand raised over the weekend, he sent a clear-as-day message to contenders in... |
 NY Post: NYPD Blotter 6h NY Post: NYPD Blotter 6h |
 | Here's which 'Harry Potter' character you are based on your zodiac sign |
| With the release of Fantastic Beasts: the Secrets of Dumbledore, find out which wizard or witch perfectly... |
 NY Post: NYPD Blotter 6h NY Post: NYPD Blotter 6h |
 | Amazon's new CEO claims warehouse worker injuries are 'misunderstood' |
| The injury rate among Amazon's warehouse employees is "sometimes misunderstood," Chief Executive Andy... |
 NY Post: NYPD Blotter 6h NY Post: NYPD Blotter 6h |
 | Heidi Montag's single-use jeans are a joke, thank goodness |
| "Single-use jeans are as stupid as the single-use plastic bottles polluting our oceans," the reality... |
 NY Post: NYPD Blotter 6h NY Post: NYPD Blotter 6h |
 | Florida Gov. DeSantis signs 15-week abortion ban into law |
| The new law signed by Florida Gov. Ron DeSantis will prohibit abortions past 15 weeks, a dramatic cut... |
 NY Post: NYPD Blotter 6h NY Post: NYPD Blotter 6h |
 | GOP state Sen. Frank Niceley invokes Hitler in message to homeless |
| State Sen. Frank Niceley invoked Adolf Hitler in a twisted attempt to tell homeless people that they... |
 NY Post: NYPD Blotter 6h NY Post: NYPD Blotter 6h |
 | 'The View' Bemoans "Cult Of Celebrity" Candidates Dr. Oz, Herschel Walker: "Anything... |
| They feel Donald Trump opened Pandora's Box for celebrity politics. |
 NY Post: NYPD Blotter 6h NY Post: NYPD Blotter 6h |
 | What Time Will 'Choose or Die' Be on Netflix? How to Watch the Horror Movie |
| Game on. |
 NY Post: NYPD Blotter 6h NY Post: NYPD Blotter 6h |
 | Tesla 'Boombox' feature prompts second recall of 595,000 vehicles |
| Tesla is recalling nearly nearly 595,000 vehicles in the US, most for a second time, because a "Boombox"... |
 NY Post: NYPD Blotter 6h NY Post: NYPD Blotter 6h |
 | Why accused Brooklyn subway shooter Frank James can be tried as a terrorist |
| The evidence against Frank James appears overwhelming, but he will get his day in court just like every... |
 NY Post: NYPD Blotter 6h NY Post: NYPD Blotter 6h |
 | Dollar Tree recalls 1 million hot glue guns over fire, burn hazards |
| More than 1 million hot glue guns sold at Dollar Tree and Family Dollar stores nationwide are being recalled over... |
 NY Post: NYPD Blotter 6h NY Post: NYPD Blotter 6h |
 | Phillies fan launches Mets fan's phone in stadium encounter |
| A Mets fan's overzealous, game-day celebrations didn't exactly sit well with a Phillies supporter this... |
 NY Post: NYPD Blotter 6h NY Post: NYPD Blotter 6h |
 | 'Not So Pretty' Is Changing the Investigative Documentary Game |
| This deep dive into the beauty industry makes taking action easy. |
 NY Post: NYPD Blotter 6h NY Post: NYPD Blotter 6h |
 | Earliest evidence of Maya calendar found inside Guatemalan pyramid |
| The fragments were found at the San Bartolo archeological site in the jungles of northern Guatemala,... |
 NY Post: NYPD Blotter 6h NY Post: NYPD Blotter 6h |
| Virginia State Police warning residents of scammers posing as law enforcement over... |
| Virginia State Police warning residents of scammers posing as law enforcement over the phone WWBT |
 "police" - Google News 7h "police" - Google News 7h |
| 405 Freeway police shooting: Southbound lanes through Sepulveda Pass shut down for... |
| 405 Freeway police shooting: Southbound lanes through Sepulveda Pass shut down for hours after officers... |
 "police" - Google News 7h "police" - Google News 7h |
| Is the San Francisco Police Department actually understaffed? Here's what the data... |
| Is the San Francisco Police Department actually understaffed? Here's what the data shows San Francisco... |
 "police" - Google News 7h "police" - Google News 7h |
| Police seek help identifying shooting suspect - KLAS - 8 News Now |
| Police seek help identifying shooting suspect KLAS - 8 News Now |
 "police" - Google News 7h "police" - Google News 7h |
| Helicopters, drones search Georgia river for missing Carmel mom - FOX 59 Indianapolis |
| Helicopters, drones search Georgia river for missing Carmel mom FOX 59 Indianapolis |
 "police" - Google News 7h "police" - Google News 7h |
| Community, police searching for missing autistic teen in Coral Springs - WPLG Local... |
| Community, police searching for missing autistic teen in Coral Springs WPLG Local 10 |
 "police" - Google News 7h "police" - Google News 7h |
| Ark. police chase ends in Memphis after bank robbery - WREG NewsChannel 3 |
| Ark. police chase ends in Memphis after bank robbery WREG NewsChannel 3 |
 "police" - Google News 7h "police" - Google News 7h |
| Police release charges for man arrested after three-state chase - theday.com |
| Police release charges for man arrested after three-state chase theday.com |
 "police" - Google News 7h "police" - Google News 7h |
| Police: Drugs, guns found in Campbell raid - WKBN.com |
| Police: Drugs, guns found in Campbell raid WKBN.com |
 "police" - Google News 7h "police" - Google News 7h |
| Police: Tarentum couple accused of child abuse after 5-month-old found to have broken... |
| Police: Tarentum couple accused of child abuse after 5-month-old found to have broken bones TribLIVE |
 "police" - Google News 7h "police" - Google News 7h |
| Lansing police investigate homicide of 27-year-old man - Lansing State Journal |
| Lansing police investigate homicide of 27-year-old man Lansing State Journal |
 "police" - Google News 7h "police" - Google News 7h |
| City police calls - April 14 - The Republic |
| City police calls - April 14 The Republic |
 "police" - Google News 7h "police" - Google News 7h |
| Woman 'forgets' to self-scan several items at Giant Eagle: Solon Police Blotter -... |
| Woman 'forgets' to self-scan several items at Giant Eagle: Solon Police Blotter cleveland.com |
 "police" - Google News 7h "police" - Google News 7h |
| Hundreds in Chicago police ranks still unvaccinated despite deadline - Chicago Tribune |
| Hundreds in Chicago police ranks still unvaccinated despite deadline Chicago Tribune |
 "police" - Google News 7h "police" - Google News 7h |
| Video NYPD says subway shooting suspect called tip line himself - ABC News |
| Video NYPD says subway shooting suspect called tip line himself ABC News |
 "NYPD" - Google News 7h "NYPD" - Google News 7h |
| Harlem honor for NYPD's Phil Cardillo, 50 years after deadly mosque shooting - PIX11 |
| Harlem honor for NYPD's Phil Cardillo, 50 years after deadly mosque shooting PIX11 |
 "NYPD" - Google News 7h "NYPD" - Google News 7h |
| Special meeting on Ithaca police reform yields few further answers - The Ithaca Voice |
| Special meeting on Ithaca police reform yields few further answers The Ithaca Voice |
 "police" - Google News 7h "police" - Google News 7h |
| Fugitive who escaped Ohio police steals SUV in Bedford Township, disappears before... |
| Fugitive who escaped Ohio police steals SUV in Bedford Township, disappears before deputies arrive WDIV... |
 "police" - Google News 7h "police" - Google News 7h |
| Goldsboro police searching for missing man - WITN |
| Goldsboro police searching for missing man WITN |
 "police" - Google News 7h "police" - Google News 7h |
| Scottsdale school threats came from UK teen, police say - Arizona's Family |
| Scottsdale school threats came from UK teen, police say Arizona's Family |
 "police" - Google News 7h "police" - Google News 7h |
| Atlanta police announce major arrests made in violent crime cases - CBS 46 News |
| Atlanta police announce major arrests made in violent crime cases CBS 46 News |
 "police" - Google News 7h "police" - Google News 7h |
| "We Ready" rapper Archie Eversole shot, killed by his brother, DeKalb police say... |
| "We Ready" rapper Archie Eversole shot, killed by his brother, DeKalb police say WSB Atlanta |
 "police" - Google News 7h "police" - Google News 7h |
| Eugene man sentenced to nearly 11 years for shooting at police during 12-hour standoff... |
| Eugene man sentenced to nearly 11 years for shooting at police during 12-hour standoff The Register-Guard |
 "police" - Google News 7h "police" - Google News 7h |
| Man arrested for impersonating federal marshal, trying to steal car, police say -... |
| Man arrested for impersonating federal marshal, trying to steal car, police say KTUL |
 "police" - Google News 7h "police" - Google News 7h |
 | Michael Conforto's market, Frankie Montas trade possibility and more MLB news |
| The Post's Jon Heyman delivers news and notes from around MLB. |
 NY Post: NYPD Blotter 8h NY Post: NYPD Blotter 8h |
 | Alec Baldwin responds to people asking 'why' he keeps having children |
| The "30 Rock" alum and wife Hillary "Hilaria" Baldwin are expecting their seventh child together. He's... |
 NY Post: NYPD Blotter 8h NY Post: NYPD Blotter 8h |
 | Best inflatable pools for summer 2022: 8 options for the whole family |
| It's time to bring out the sunscreen, swimsuits and inflatable pools! |
 NY Post: NYPD Blotter 8h NY Post: NYPD Blotter 8h |
 | Grimes poses nude for Dion Lee campaign: 'Medieval sci-fi energy' |
| "I've been a big fan of Dion for a long time! His work looks like it exists in 'Dune.' Medieval sci-fi... |
 NY Post: NYPD Blotter 8h NY Post: NYPD Blotter 8h |
 | Trying the Isle of Paradise tanning drops and tanning water: our review |
| Rain or shine, here's how to have a tan all year long. |
 NY Post: NYPD Blotter 8h NY Post: NYPD Blotter 8h |
 | Inside the return of the USFL's New Jersey Generals: familiar name, new era, same... |
| The USFL was lost to history, and a $3.76 settlement. Now reincarnated, with much more modest goals,... |
 NY Post: NYPD Blotter 8h NY Post: NYPD Blotter 8h |
 | John Travolta honors late son Jett on what would've been 30th birthday |
| Jett died at the age of 16 in 2009 after suffering a seizure during a trip to the Bahamas. Travolta shared... |
 NY Post: NYPD Blotter 8h NY Post: NYPD Blotter 8h |
 | Why Mets are the biggest winners of MLB's long winter |
| In this wild winter with two frenzied acquisition sessions, there were some clear winners, some stark... |
 NY Post: NYPD Blotter 8h NY Post: NYPD Blotter 8h |
 | Where to Watch 'Soundtrack #1' K-Drama Series |
| When will Americans get to see this new Korean romance? |
 NY Post: NYPD Blotter 8h NY Post: NYPD Blotter 8h |
 | Read Elon Musk's text, voice messages to Twitter ahead of takeover offer |
| The SEC filing detailing Elon Musk's offer Thursday to buy Twitter at $54.20 per share reveals details... |
 NY Post: NYPD Blotter 8h NY Post: NYPD Blotter 8h |
 | Video seems to show alleged NYC shooter Frank James walk through Sunset Park |
| Video captured moments after the accused terrorist allegedly opened fire on a subway car appears to show... |
 NY Post: NYPD Blotter 8h NY Post: NYPD Blotter 8h |
 | Teen shot in back during spate of overnight violence in NYC |
| The gunplay began around 6:35 p.m. Wednesday, when a 17-year-old was struck in the back at the corner... |
 NY Post: NYPD Blotter 8h NY Post: NYPD Blotter 8h |
 | Patrick Beverley's girlfriend, Mandana Bolourchi, celebrates Timberwolves' playoff... |
| The Iranian-born fashion entrepreneur took to Instagram to congratulate Beverley, who led the Timberwolves... |
 NY Post: NYPD Blotter 8h NY Post: NYPD Blotter 8h |
 | Stream It Or Skip It: 'The Kardashians' On Hulu, A New Series That Treads The Exact... |
| What, were you expecting the Kardashians and Jenners to sit around playing chess? |
 NY Post: NYPD Blotter 8h NY Post: NYPD Blotter 8h |
 | Goldman Sachs profit slumps 42 percent despite strong trading revenue |
| Goldman Sachs reported first quarter earnings Thursday that crushed analyst expectations — even as the... |
 NY Post: NYPD Blotter 8h NY Post: NYPD Blotter 8h |
 | David Lee built a winner out of NYCFC — now he wants to keep them there |
| The executive knows a sustainable model is needed alongside spending; even if you nail all of your signings,... |
 NY Post: NYPD Blotter 8h NY Post: NYPD Blotter 8h |
 | Mexican woman dies after getting 'trapped upside down' on border fence |
| The 32-year-old woman died after she got stuck upside down trying to scale the US border fence. She was... |
 NY Post: NYPD Blotter 8h NY Post: NYPD Blotter 8h |
 | Kim Kardashian broke news of Tristan Thompson's paternity suit to Khloé |
| Khloé said in a new interview that the pain "doesn't get easier," but she has become "more numb" to Thompson... |
 NY Post: NYPD Blotter 8h NY Post: NYPD Blotter 8h |
 | Twitter HQ meltdown: Internet pokes fun at employees over Musk takeover |
| Panic, dread, doom, and gloom were the themes of memes posted online as "Twitter HQ" was trending all... |
 NY Post: NYPD Blotter 8h NY Post: NYPD Blotter 8h |
| Do You Know Who Your County Sheriff Is? |
| According to a newly released survey by the ACLU of Massachusetts, 83 percent of state residents can't... |
 The Crime Report 8h The Crime Report 8h |
| Police investigate shooting at Daytona Beach apartment complex - WKMG News 6 & ClickOrlando |
| Police investigate shooting at Daytona Beach apartment complex WKMG News 6 & ClickOrlando |
 "police" - Google News 8h "police" - Google News 8h |
| Virginia police routinely use secret GPS pings to track people's cell phones - Inside... |
| Virginia police routinely use secret GPS pings to track people's cell phones Inside NoVA |
 "police" - Google News 8h "police" - Google News 8h |
| State Police investigating deadly officer-involved shooting in Lafayette - WBRZ |
| State Police investigating deadly officer-involved shooting in Lafayette WBRZ |
 "police" - Google News 8h "police" - Google News 8h |
| 27-year-old shot, stabbed in critical but stable condition: Florence Police - WHNT... |
| 27-year-old shot, stabbed in critical but stable condition: Florence Police WHNT News 19 |
 "police" - Google News 8h "police" - Google News 8h |
| HPD officer injured after being rear-ended off-duty Pasadena officer along Beltway... |
| HPD officer injured after being rear-ended off-duty Pasadena officer along Beltway 8, police say KHOU.com |
 "police" - Google News 8h "police" - Google News 8h |
| St. Pete police asking for tips in two recent fatal shootings - Bay News 9 |
| St. Pete police asking for tips in two recent fatal shootings Bay News 9 |
 "police" - Google News 8h "police" - Google News 8h |
| Bodycam footage of Maplewood police handcuffing kids released - KSTP |
| Bodycam footage of Maplewood police handcuffing kids released KSTP |
 "police" - Google News 8h "police" - Google News 8h |
| NYC Considering Weapons Detection Tech for Subway System |
| The recent subway mass shooting has prompted New York City to investigate the use of weapon-detection... |
 The Crime Report 8h The Crime Report 8h |
| Video Released of Deadly Michigan Traffic Stop |
| The violent climax of a traffic stop, brief foot chase and struggle over a stun gun resulted in Patrick... |
 The Crime Report 8h The Crime Report 8h |
| San Francisco's Swollen Trial Backlogs Are Trapping People Behind Bars |
| Nearly a quarter of incarcerated people awaiting their day in court in San Francisco county are being... |
 The Crime Report 8h The Crime Report 8h |
| Police situation, brief lockdown delay morning bus pickups for Riverview schools... |
| Police situation, brief lockdown delay morning bus pickups for Riverview schools WDIV ClickOnDetroit |
 "police" - Google News 8h "police" - Google News 8h |
| Police arrest man accused of breaking into Audrain Community Hospital - ABC17NEWS... |
| Police arrest man accused of breaking into Audrain Community Hospital - ABC17NEWS ABC17News.com |
 "police" - Google News 8h "police" - Google News 8h |
| Cincinnati police release body camera footage of Covington shooting - The Cincinnati... |
| Cincinnati police release body camera footage of Covington shooting The Cincinnati Enquirer |
 "police" - Google News 8h "police" - Google News 8h |
| Police release photos of missing Region girl; tips sought on suspected runaway -... |
| Police release photos of missing Region girl; tips sought on suspected runaway The Times of Northwest... |
 "police" - Google News 8h "police" - Google News 8h |
| UPDATE: Suspect who shot at Thomasville police officer captured - WCTV |
| UPDATE: Suspect who shot at Thomasville police officer captured WCTV |
 "police" - Google News 8h "police" - Google News 8h |
| Police in Schools: Does Their Harm Outweigh Safety Risks? |
| At a time when cities such as Alexandria, Virginia, Washington, and Milwaukee are wrestling with whether... |
 The Crime Report 9h The Crime Report 9h |
| The News Media Names Mass Shooters Less Often: Study |
| For the past 10 years, the news media has followed the example of law enforcement by reducing the number... |
 The Crime Report 9h The Crime Report 9h |
| Delaware State Police Troop 5 Hosting Community Café - Delaware.gov |
| Delaware State Police Troop 5 Hosting Community Café Delaware.gov |
 "police" - Google News 9h "police" - Google News 9h |
| Northern Regional Police department promotes first woman to rank of sergeant - TribLIVE |
| Northern Regional Police department promotes first woman to rank of sergeant TribLIVE |
 "police" - Google News 9h "police" - Google News 9h |
| 'A multi-layered issue': Woodward, Spokane police to form task force aimed at rise... |
| 'A multi-layered issue': Woodward, Spokane police to form task force aimed at rise in gun violence The... |
 "police" - Google News 9h "police" - Google News 9h |
| Multiple police units called in search of repeat armed robber in North Miami neighborhood... |
| Multiple police units called in search of repeat armed robber in North Miami neighborhood WSVN 7News... |
 "police" - Google News 9h "police" - Google News 9h |
| Florida man impersonates police for discount at Wendy's - WPLG Local 10 |
| Florida man impersonates police for discount at Wendy's WPLG Local 10 |
 "police" - Google News 9h "police" - Google News 9h |
| Police called to Lebanon home had no time to react before burglar opened fire, killing... |
| Police called to Lebanon home had no time to react before burglar opened fire, killing officer: DA PennLive |
 "police" - Google News 9h "police" - Google News 9h |
 | There's still a way to reach global goal on climate change |
| The world is potentially on track to keep global warming at, or a shade below, 2 degrees Celsius (3.6... |
 NY Post: NYPD Blotter 9h NY Post: NYPD Blotter 9h |
 | White House mulls sending top official to Kyiv after Euro leaders visit: report |
| Among those being considered to pay a "surprise" visit to Volodymyr Zelensky in Kyiv are Secretary of... |
 NY Post: NYPD Blotter 9h NY Post: NYPD Blotter 9h |
 | NYC subway shooting suspect Frank James to face court on terror charges |
| Subway shooting suspect Frank James is set to face federal court Thursday for allegedly turning a New... |
 NY Post: NYPD Blotter 9h NY Post: NYPD Blotter 9h |
 | Baker Mayfield's podcast comments about booing fans haven't gone over well |
| The backlash from Baker Mayfield's latest interview continues to mount after the Browns quarterback said... |
 NY Post: NYPD Blotter 9h NY Post: NYPD Blotter 9h |
 | Ex-WH chief of staff Meadows off North Carolina voter rolls during fraud probe |
| Mark Meadows was removed from North Carolina's voter rolls this week amid a state investigation into... |
 NY Post: NYPD Blotter 9h NY Post: NYPD Blotter 9h |
 | NBA betting: Trust these strategies for wagering on playoffs |
| These three techniques are a solid foundation to guide your NBA playoffs betting. |
 NY Post: NYPD Blotter 9h NY Post: NYPD Blotter 9h |
 | There's one 'silly' accusation Urban Meyer won't stand for |
| During a recent appearance on the "The Tim May Podcast," the former Jaguars head coach addressed claims... |
 NY Post: NYPD Blotter 9h NY Post: NYPD Blotter 9h |
 | Ben Affleck's dad didn't know about Jennifer Lopez engagement |
| Timothy Affleck said in a new interview that he has not talked to Bennifer 2.0 "in ages," but he is "happy"... |
 NY Post: NYPD Blotter 9h NY Post: NYPD Blotter 9h |
| Makeup brushes are dirtier than toilets, disgusting microscopic photos show |
| An alarming new UK study revealed that makeup brushes can be dirtier than a toilet. |
 NY Post: NYPD Blotter 9h NY Post: NYPD Blotter 9h |
 | Woman saved after using secret TikTok signal to alert cashier about her kidnapping |
| The Hickman County woman put her palm forward, tucked her thumb in and closed her four fingers over it... |
 NY Post: NYPD Blotter 9h NY Post: NYPD Blotter 9h |
 | Price of Elon Musk's Twitter bid is yet another '420' pot joke |
| Leave it to Elon Musk to slip a weed joke into his $43 billion bid to buy Twitter. |
 NY Post: NYPD Blotter 9h NY Post: NYPD Blotter 9h |
 | Charles Barkley drags the Nets: 'They can't beat the Celtics' |
| While discussing the game on TNT's "Inside the NBA," Barkley argued that Brooklyn's performance proved... |
 NY Post: NYPD Blotter 9h NY Post: NYPD Blotter 9h |
 | 'Euphoria' star Chloe Cherry 'used to have a bunch' of sugar daddies |
| The actress and former porn star, 24, explained on the "Viall Files" podcast Wednesday that the transactional... |
 NY Post: NYPD Blotter 9h NY Post: NYPD Blotter 9h |
 | Harry and Meghan need to turn Invictus Games into a 'win' for reputations |
| After missing Prince Philip's memorial in the UK in March, Prince Harry and Meghan Markle need to do... |
 NY Post: NYPD Blotter 9h NY Post: NYPD Blotter 9h |
 | 'Grease' actor Eddie Deezen arrested for burglary, trespassing |
| Deezen, who played nerd Eugene Felsnic in the 1978 movie and its 1982 sequel, allegedly refused to leave... |
 NY Post: NYPD Blotter 9h NY Post: NYPD Blotter 9h |
 | Gilbert Gottfried's pals reveal shocking jokes he made about his own death |
| Penn Jillette, Judy Gold and other comedians reveal the shocking jokes Gilbert Gottfried, who died April... |
 NY Post: NYPD Blotter 9h NY Post: NYPD Blotter 9h |
 | Tearful Ukrainian refugees reunite with loved ones at US-Mexico border |
| Ukrainian refugees wiped their tears as they hugged their loved ones at the US-Mexico border following... |
 NY Post: NYPD Blotter 9h NY Post: NYPD Blotter 9h |
 | 'Star Trek: Picard' Casts 'Battlestar Galactica' Vet James Callis As Picard's [SPOILER] |
| James Callis' secret role... Revealed! |
 NY Post: NYPD Blotter 9h NY Post: NYPD Blotter 9h |
 | The many doubts hanging over Kayvon Thibodeaux's Giants NFL Draft visit |
| The edge rusher from Oregon meets with the Giants on Thursday at the team facility. This top-30 visit... |
 NY Post: NYPD Blotter 9h NY Post: NYPD Blotter 9h |
| Woman shot in head sitting in Bronx car as shootings continue to plague NYC - PIX11 |
| Woman shot in head sitting in Bronx car as shootings continue to plague NYC PIX11 |
 "NYPD" - Google News 9h "NYPD" - Google News 9h |
| NYPD officer shot with BB gun in Queens - 1010 WINS |
| NYPD officer shot with BB gun in Queens 1010 WINS |
 "NYPD" - Google News 9h "NYPD" - Google News 9h |
| Parks Police, Secret Service Agree on New Use-of-Force Guidelines in DOJ Settlement |
| The U.S. Parks Service and Secret Service have agreed to strict new guidelines on the use of force during... |
 The Crime Report 9h The Crime Report 9h |
| U.S. Warns Energy Plants of Potential Sabotage by Newly Discovered Malware |
| U.S. officials have announced the discovery of an alarmingly sophisticated and effective system for attacking... |
 The Crime Report 9h The Crime Report 9h |
| Indonesia Outlaws Sexual Abuse and Forced Marriage |
| For the first time, Indonesia has passed a landmark bill that outlaws forced marriage and sexual abuse,... |
 The Crime Report 9h The Crime Report 9h |
| Man standing on train tracks struck by train, police say - KSAT San Antonio |
| Man standing on train tracks struck by train, police say KSAT San Antonio |
 "police" - Google News 9h "police" - Google News 9h |
| Police activity prompts 405 Freeway closure through Sepulveda Pass - KTLA Los Angeles |
| Police activity prompts 405 Freeway closure through Sepulveda Pass KTLA Los Angeles |
 "police" - Google News 9h "police" - Google News 9h |
| Deer caused central Pa. crash that killed passenger: state police - PennLive |
| Deer caused central Pa. crash that killed passenger: state police PennLive |
 "police" - Google News 9h "police" - Google News 9h |
| Police: No one found in Dedham home after report of armed man prompts tense standoff... |
| Police: No one found in Dedham home after report of armed man prompts tense standoff Boston News, Weather,... |
 "police" - Google News 9h "police" - Google News 9h |
| Texas City police see connections between two recent shootings - Galveston County... |
| Texas City police see connections between two recent shootings Galveston County Daily News |
 "police" - Google News 9h "police" - Google News 9h |
| Police identify remains of missing 8-year-old boy; nationwide arrest warrant includes... |
| Police identify remains of missing 8-year-old boy; nationwide arrest warrant includes father WCAX |
 "police" - Google News 9h "police" - Google News 9h |
| Park Police, Secret Service Will Institute New Protest Policing Policies Following... |
| Park Police, Secret Service Will Institute New Protest Policing Policies Following Lafayette Park Clearing DCist |
 "police" - Google News 9h "police" - Google News 9h |
| Vergennes Police Log: Sergeant helps woman walking in traffic - Addison County Independent |
| Vergennes Police Log: Sergeant helps woman walking in traffic Addison County Independent |
 "police" - Google News 10h "police" - Google News 10h |
| Middlebury Police Log: Police investigate possible assault - Addison County Independent |
| Middlebury Police Log: Police investigate possible assault Addison County Independent |
 "police" - Google News 10h "police" - Google News 10h |
| Virginia State Police issue Senior Alert for 73-year-old Nottoway woman - WRIC ABC... |
| Virginia State Police issue Senior Alert for 73-year-old Nottoway woman WRIC ABC 8News |
 "police" - Google News 10h "police" - Google News 10h |
| Police presence on school grounds poses potential risks to kids - The Conversation |
| Police presence on school grounds poses potential risks to kids The Conversation |
 "police" - Google News 10h "police" - Google News 10h |
| Scoop: Confidential memos raise new questions about Denver police response to George... |
| Scoop: Confidential memos raise new questions about Denver police response to George Floyd protests Axios |
 "police" - Google News 10h "police" - Google News 10h |
| Police: One dead, one rescued after hourslong armed standoff in Guilford - New Haven... |
| Police: One dead, one rescued after hourslong armed standoff in Guilford New Haven Register |
 "police" - Google News 10h "police" - Google News 10h |
| Lansing Police investigate early morning homicide on Beal Ave. - WILX |
| Lansing Police investigate early morning homicide on Beal Ave. WILX |
 "police" - Google News 10h "police" - Google News 10h |
| New Mexico State Police confirm 2 people killed in large Ruidoso wildfire - KVIA |
| New Mexico State Police confirm 2 people killed in large Ruidoso wildfire KVIA |
 "police" - Google News 10h "police" - Google News 10h |
| Man charged after three church break-ins, police say - WREG NewsChannel 3 |
| Man charged after three church break-ins, police say WREG NewsChannel 3 |
 "police" - Google News 10h "police" - Google News 10h |
| 'Club Penguin Rewritten' shut down by Disney, website seized by London police - TechCrunch |
| 'Club Penguin Rewritten' shut down by Disney, website seized by London police TechCrunch |
 "police" - Google News 10h "police" - Google News 10h |
| Lebanon Police search for suspect following shooting near school - WSMV 4 |
| Lebanon Police search for suspect following shooting near school WSMV 4 |
 "police" - Google News 10h "police" - Google News 10h |
| California cities spent huge share of federal Covid relief funds on police - The... |
| California cities spent huge share of federal Covid relief funds on police The Guardian |
 "police" - Google News 10h "police" - Google News 10h |
 | How Gilbert Gottfried kept working, being a 'know-it-all' up until his death |
| Gottfried used his signature sandpaper voice to keep people laughing — right up until his death this... |
 NY Post: NYPD Blotter 11h NY Post: NYPD Blotter 11h |
 | Frank Langella fired by Netflix after sexual misconduct allegations |
| Frank Langella was accused of sexual harassment toward a female co-star on the set of the Netflix series... |
 NY Post: NYPD Blotter 11h NY Post: NYPD Blotter 11h |
 | Kim Kardashian appears to Photoshop Pete Davidson's nose and jawline |
| Just one day after Khloé Kardashian was forced to admit she superimposed her daughter into photos, the... |
 NY Post: NYPD Blotter 11h NY Post: NYPD Blotter 11h |
 | City to expand Gifted and Talented program to more students, districts |
| They also promised to extend Gifted and Talented to more districts and rework how the city assesses young... |
 NY Post: NYPD Blotter 11h NY Post: NYPD Blotter 11h |
 | 'The Kardashians' Episode Guide: How Many Episodes in the New Hulu Series? |
| They're back! |
 NY Post: NYPD Blotter 11h NY Post: NYPD Blotter 11h |
 | Europa League predictions: Expect high scores in Leipzig vs. Atalanta |
| Expect high-scoring affairs in these Europa League quarterfinals matchups... |
 NY Post: NYPD Blotter 11h NY Post: NYPD Blotter 11h |
 | Apple's 'Roar' is a feminist black mirror with Nicole Kidman, Issa Rae |
| The new Apple TV+ series "Roar" is essentially a star-studded version of "Black Mirror" with a feminist... |
 NY Post: NYPD Blotter 11h NY Post: NYPD Blotter 11h |
 | Video shows man fall from helicopter as 3 die in doomed rescue in India |
| The man was among three people who plunged to their deaths, officials told local media, while 12 others... |
 NY Post: NYPD Blotter 11h NY Post: NYPD Blotter 11h |
 | Thandiwe Newton denies being fired from 'Magic Mike' over Channing Tatum fight |
| The actress was rumored to have been in a heated spat with Channing Tatum over Will Smith's infamous... |
 NY Post: NYPD Blotter 11h NY Post: NYPD Blotter 11h |
 | If the Knicks' Donovan Mitchell dream is to come true this summer, here's what it... |
| If the Knicks are going to have a chance at Donovan Mitchell, it'll take a messy Jazz divorce and a godfather... |
 NY Post: NYPD Blotter 11h NY Post: NYPD Blotter 11h |
 | Ridiculous twist throws Netflix's 'Anatomy of a Scandal' off the rails |
| Netflix anthology features terrific acting and an absorbing, multi-layered storyline -- until it careens... |
 NY Post: NYPD Blotter 11h NY Post: NYPD Blotter 11h |
 | Errol Spence Jr. brings new outlook after car crash into title fight: 'Blessed position' |
| Errol Spence Jr. needed to slow down. Everything in his life was moving at a rapid pace. Inside the ring,... |
 NY Post: NYPD Blotter 11h NY Post: NYPD Blotter 11h |
 | Russian warship involved in 'Go f–k yourself' incident badly damaged, crew evacuated |
| Ukraine claimed it struck the 610-foot missile cruiser Moskva with two Neptune missiles, but Moscow blamed... |
 NY Post: NYPD Blotter 11h NY Post: NYPD Blotter 11h |
 | How the confusing, unnecessary NBA play-in has become one of the most engaging tournaments... |
| Outside of college football, no major American sport demonstrates the need for an expanded playoff. Yet,... |
 NY Post: NYPD Blotter 11h NY Post: NYPD Blotter 11h |
 | Comedy legends pay tribute to iconic funnyman Gilbert Gottfried |
| "Nobody made me laugh so hard. He was a wonderful pal and a great dad," Jeff Ross wrote. |
 NY Post: NYPD Blotter 11h NY Post: NYPD Blotter 11h |
| Man shot at, grazed by bullet during argument; woman detained, police say - KSAT... |
| Man shot at, grazed by bullet during argument; woman detained, police say KSAT San Antonio |
 "police" - Google News 11h "police" - Google News 11h |
| Police release bodycam video of hostage standoff shooting in Tierrasanta - FOX 5... |
| Police release bodycam video of hostage standoff shooting in Tierrasanta FOX 5 San Diego |
 "police" - Google News 11h "police" - Google News 11h |
| I-Team: Las Vegas police could solve 'unbelievable' amount of crime if traffic cameras... |
| I-Team: Las Vegas police could solve 'unbelievable' amount of crime if traffic cameras recorded, homicide... |
 "police" - Google News 11h "police" - Google News 11h |
| Fmr. Wellford Police lieutenant selected as new Duncan Police Chief - WSPA 7News |
| Fmr. Wellford Police lieutenant selected as new Duncan Police Chief WSPA 7News |
 "police" - Google News 11h "police" - Google News 11h |
| ISP: Wanted Indy man evades police, accepts ride and is driven right back - WANE |
| ISP: Wanted Indy man evades police, accepts ride and is driven right back WANE |
 "police" - Google News 11h "police" - Google News 11h |
| Police: Man struck on head with machete at Penn Station subway stop - WABC-TV |
| Police: Man struck on head with machete at Penn Station subway stop WABC-TV |
 "police" - Google News 11h "police" - Google News 11h |
| Eric Whiteside appointed new deputy chief of University Police, Hahn to retire April... |
| Eric Whiteside appointed new deputy chief of University Police, Hahn to retire April 30 OSU - The Lantern |
 "police" - Google News 11h "police" - Google News 11h |
| Man arrested for allegedly fleeing police, driving recklessly across western Dane... |
| Man arrested for allegedly fleeing police, driving recklessly across western Dane Co. Channel3000.com... |
 "police" - Google News 11h "police" - Google News 11h |
| Suspected bank robber arrested 'almost immediately' by Florissant police - KMOV4 |
| Suspected bank robber arrested 'almost immediately' by Florissant police KMOV4 |
 "police" - Google News 11h "police" - Google News 11h |
 | Gun-Free School Zones and Concealed Carry: Which Takes Precedence? |
| Photo by Jared Spool via Flickr Do state laws permitting individuals to carry concealed weapons undermine... |
 The Crime Report 12h The Crime Report 12h |
 | The 'Robotic Revolution' in Public Safety |
| Digit, a bipedal robot from Agility Robotics, being tested at the University of Michigan. Photo by Joseph... |
 The Crime Report 12h The Crime Report 12h |
| Police searching for hit-and-run suspect - Eyewitness News 3 |
| Police searching for hit-and-run suspect Eyewitness News 3 |
 "police" - Google News 12h "police" - Google News 12h |
| Dayton police announce major reorganization plan with more officers moved to patrol... |
| Dayton police announce major reorganization plan with more officers moved to patrol division WHIO |
 "police" - Google News 12h "police" - Google News 12h |
| Police identify remains of missing 8-year-old boy; nationwide arrest warrant includes... |
| Police identify remains of missing 8-year-old boy; nationwide arrest warrant includes father WLOX |
 "police" - Google News 12h "police" - Google News 12h |
| Wilder man arrested after police, federal agents descend on home - vtdigger.org |
| Wilder man arrested after police, federal agents descend on home vtdigger.org |
 "police" - Google News 12h "police" - Google News 12h |
| Police: 2 people carjacked in Pittsburgh, suspects take off with 1 person still inside... |
| Police: 2 people carjacked in Pittsburgh, suspects take off with 1 person still inside WPXI Pittsburgh |
 "police" - Google News 12h "police" - Google News 12h |
 | Elon Musk offers to buy Twitter for $41 billion |
| Elon Musk has offered to buy Twitter for about $41 billion, just days after rejecting a seat on the social... |
 NY Post: NYPD Blotter 12h NY Post: NYPD Blotter 12h |
 | Let her eat cake: World's oldest gorilla Fatou turns 65 at Berlin Zoo |
| Happy birthday, Fatou! At 65, Berlin Zoo's famous female gorilla is the oldest of her kind. She rang... |
 NY Post: NYPD Blotter 12h NY Post: NYPD Blotter 12h |
 | Faces of the Gilgo Beach murder victims |
| After 10 years and no arrests, some are wondering if the victims will ever get justice. |
 NY Post: NYPD Blotter 12h NY Post: NYPD Blotter 12h |
 | JP Morgan Chase unveils its new Park Avenue headquarters tower |
| The financial giant run by Jamie Dimon on Thursday unveiled the long-secret design of its new, 1,388-feet-tall... |
 NY Post: NYPD Blotter 12h NY Post: NYPD Blotter 12h |
 | Person shot at rapper DaBaby's North Carolina estate |
| It's reported that the property where the shooting occurred was owned by DaBaby, real name Jonathan Kirk. |
 NY Post: NYPD Blotter 12h NY Post: NYPD Blotter 12h |
| NYPD: Suspects stealing catalytic converters caused Belt Parkway shutdown - News... |
| NYPD: Suspects stealing catalytic converters caused Belt Parkway shutdown News 12 Westchester |
 "NYPD" - Google News 12h "NYPD" - Google News 12h |
| Police Charge At Fans After Clashes Between Chelsea And Man City Followers In Madrid... |
| Police Charge At Fans After Clashes Between Chelsea And Man City Followers In Madrid Sports Illustrated |
 "police" - Google News 12h "police" - Google News 12h |
| Robbinsdale councilmember charged in DWI police chase completes rehab - FOX 9 Minneapolis-St.... |
| Robbinsdale councilmember charged in DWI police chase completes rehab FOX 9 Minneapolis-St. Paul |
 "police" - Google News 12h "police" - Google News 12h |
| Police investigating suspicious death in New Scotland - NEWS10 ABC |
| Police investigating suspicious death in New Scotland NEWS10 ABC |
 "police" - Google News 12h "police" - Google News 12h |
| Former deputy police chief returning to work as a chief - News-Gazette.com |
| Former deputy police chief returning to work as a chief News-Gazette.com |
 "police" - Google News 12h "police" - Google News 12h |
| Prison's Wounded Healers |
| Shawanna Vaughn fights prisons with equal amounts of forgiveness and fury. The forgiveness she offers... |
 The Crime Report 12h The Crime Report 12h |
| Teen shot in chest during altercation at South Side apartment, police say - KSAT... |
| Teen shot in chest during altercation at South Side apartment, police say KSAT San Antonio |
 "police" - Google News 13h "police" - Google News 13h |
| Child ejected, injured in Johnstown crash; police investigating - WJAC Johnstown |
| Child ejected, injured in Johnstown crash; police investigating WJAC Johnstown |
 "police" - Google News 13h "police" - Google News 13h |
| Police: Girl injured in east Columbus crash - 10TV |
| Police: Girl injured in east Columbus crash 10TV |
 "police" - Google News 13h "police" - Google News 13h |
| Oxford police search for suspects in separate armed robberies - FOX19 |
| Oxford police search for suspects in separate armed robberies FOX19 |
 "police" - Google News 13h "police" - Google News 13h |
| Andre Sayegh addresses long-awaited police audit — while Paterson police chief is... |
| Andre Sayegh addresses long-awaited police audit — while Paterson police chief is absent NorthJersey.com |
 "police" - Google News 13h "police" - Google News 13h |
| 'We are devastated': 2 puppies stolen at gunpoint in DC, police looking for 4 men... |
| 'We are devastated': 2 puppies stolen at gunpoint in DC, police looking for 4 men WJLA |
 "police" - Google News 13h "police" - Google News 13h |
| Richmond Police search for suspect in double shooting on city's southside - WWBT |
| Richmond Police search for suspect in double shooting on city's southside WWBT |
 "police" - Google News 13h "police" - Google News 13h |
| Man dead, another injured following shooting in Maryvale, Phoenix Police say - FOX... |
| Man dead, another injured following shooting in Maryvale, Phoenix Police say FOX 10 News Phoenix |
 "police" - Google News 13h "police" - Google News 13h |
| Parker police looking for missing 77-year-old - FOX 31 Denver |
| Parker police looking for missing 77-year-old FOX 31 Denver |
 "police" - Google News 13h "police" - Google News 13h |
| NYPD Started Making Arrests After 6-Hour Standoff at Homeless Encampment - VICE |
| NYPD Started Making Arrests After 6-Hour Standoff at Homeless Encampment VICE |
 "NYPD" - Google News 14h "NYPD" - Google News 14h |
| Police release video of deadly shooting during traffic stop - CNN |
| Police release video of deadly shooting during traffic stop CNN |
 "police" - Google News 14h "police" - Google News 14h |
| Police investigate deadly stabbing in SE Albuquerque - KOB |
| Police investigate deadly stabbing in SE Albuquerque KOB |
 "police" - Google News 14h "police" - Google News 14h |
| Raleigh police respond to robbery, stabbing - WRAL News |
| Raleigh police respond to robbery, stabbing WRAL News |
 "police" - Google News 14h "police" - Google News 14h |
| AG's Office Releases Video Footage Related to Fatal Police-Involved Shooting in Plainsboro... |
| AG's Office Releases Video Footage Related to Fatal Police-Involved Shooting in Plainsboro on February... |
 "police" - Google News 14h "police" - Google News 14h |
| Boy held at knifepoint by 4 robbers in the Bronx, police say - PIX11 |
| Boy held at knifepoint by 4 robbers in the Bronx, police say PIX11 |
 "NYPD" - Google News 14h "NYPD" - Google News 14h |
| Activists Call For Change After 4 Kids Handcuffed By Maplewood Police - CBS Minnesota |
| Activists Call For Change After 4 Kids Handcuffed By Maplewood Police CBS Minnesota |
 "police" - Google News 14h "police" - Google News 14h |
| Man who shot at dog walker remains at large; police still investigating Mariners... |
| Man who shot at dog walker remains at large; police still investigating Mariners Harbor incident SILive.com |
 "police" - Google News 14h "police" - Google News 14h |
| Man charged in three church break-ins, police say - FOX13 Memphis |
| Man charged in three church break-ins, police say FOX13 Memphis |
 "police" - Google News 14h "police" - Google News 14h |
| Somerville police officer wounded after 'unintentional discharge' of gun - Boston... |
| Somerville police officer wounded after 'unintentional discharge' of gun Boston 25 News |
 "police" - Google News 14h "police" - Google News 14h |
| Retired NYPD transit chief speaks about subway safety - PIX11 |
| Retired NYPD transit chief speaks about subway safety PIX11 |
 "NYPD" - Google News 15h "NYPD" - Google News 15h |
| Man's organ donation leads to 'Easter miracle' for retired NYPD officer in Jim Thorpe... |
| Man's organ donation leads to 'Easter miracle' for retired NYPD officer in Jim Thorpe 69News WFMZ-TV |
 "NYPD" - Google News 15h "NYPD" - Google News 15h |
| Police: Dog bit off woman's ear after suspect ordered animal to attack - Hawaii News... |
| Police: Dog bit off woman's ear after suspect ordered animal to attack Hawaii News Now |
 "police" - Google News 15h "police" - Google News 15h |
| Murder suspect's escape from police headquarters is highly unusual, ex-detective... |
| Murder suspect's escape from police headquarters is highly unusual, ex-detective says Fox Baltimore |
 "police" - Google News 15h "police" - Google News 15h |
| Man arrested after firing gun, running from officers in McKees Rocks, police say... |
| Man arrested after firing gun, running from officers in McKees Rocks, police say WPXI Pittsburgh |
 "police" - Google News 15h "police" - Google News 15h |
| EXCLUSIVE: Temple University Campus Police Department Operating At 60% Staffing Amid... |
| EXCLUSIVE: Temple University Campus Police Department Operating At 60% Staffing Amid Rising Crime, Union... |
 "police" - Google News 15h "police" - Google News 15h |
 | 9-year-old girl shot at California mall was waiting to see Easter Bunny |
| Little Ava Chruniak was struck by the bullets allegedly fired by Marqel Cockrell, 20, a shoe store owner... |
 NY Post: NYPD Blotter 15h NY Post: NYPD Blotter 15h |
 | Yankees' Gerrit Cole hit hard for second straight start |
| Gerrit Cole put the Yankees in another early hole, but this time it had nothing to do with Billy Crystal. |
 NY Post: NYPD Blotter 15h NY Post: NYPD Blotter 15h |
 | Buck Showalter on Mets leading MLB in hit by pitches: 'It's not funny' |
| It has gotten nearly comical, but the Mets are not laughing. The Mets finished their matinee, 9-6 victory... |
 NY Post: NYPD Blotter 15h NY Post: NYPD Blotter 15h |
| Utah transit police urge alertness after New York subway shooting - Deseret News |
| Utah transit police urge alertness after New York subway shooting Deseret News |
 "police" - Google News 15h "police" - Google News 15h |
| Former lieutenant of the South Boston Police Department indicted - WSET |
| Former lieutenant of the South Boston Police Department indicted WSET |
 "police" - Google News 15h "police" - Google News 15h |
| Police identify remains of missing 8-year-old boy; nationwide arrest warrant includes... |
| Police identify remains of missing 8-year-old boy; nationwide arrest warrant includes father Arizona's... |
 "police" - Google News 15h "police" - Google News 15h |
| Suspect fires shot during arrest by Portland police officers - Fox 12 Oregon |
| Suspect fires shot during arrest by Portland police officers Fox 12 Oregon |
 "police" - Google News 15h "police" - Google News 15h |
| NYPD: Suspect in Brooklyn subway shooting taken into custody - Spectrum News |
| NYPD: Suspect in Brooklyn subway shooting taken into custody Spectrum News |
 "NYPD" - Google News 16h "NYPD" - Google News 16h |
| Police: Walmart employees stole $25K worth of iPhones - Altoona Mirror |
| Police: Walmart employees stole $25K worth of iPhones Altoona Mirror |
 "police" - Google News 16h "police" - Google News 16h |
| Woman tased, arrested after swinging axe at cars in Concord: police - KRON4 |
| Woman tased, arrested after swinging axe at cars in Concord: police KRON4 |
 "police" - Google News 16h "police" - Google News 16h |
| Columbus police name second suspect in shooting death of Markayla Marshall - WTVM |
| Columbus police name second suspect in shooting death of Markayla Marshall WTVM |
 "police" - Google News 16h "police" - Google News 16h |
| Waco Police investigating threats against churches - KWTX |
| Waco Police investigating threats against churches KWTX |
 "police" - Google News 16h "police" - Google News 16h |
| NYPD Identifies 'Person of Interest' in Brooklyn subway shooting - Hickory Daily... |
| NYPD Identifies 'Person of Interest' in Brooklyn subway shooting Hickory Daily Record |
 "NYPD" - Google News 16h "NYPD" - Google News 16h |
| U.S. Supreme Court clears the way for unlawful arrest lawsuit against NYPD - Yahoo!... |
| U.S. Supreme Court clears the way for unlawful arrest lawsuit against NYPD Yahoo! Voices |
 "NYPD" - Google News 16h "NYPD" - Google News 16h |
| Man attacks victim with machete at Penn Station: NYPD - PIX11 |
| Man attacks victim with machete at Penn Station: NYPD PIX11 |
 "NYPD" - Google News 16h "NYPD" - Google News 16h |
| Police chief: Stolen vehicle with child inside crashes in Tarrytown; suspects on... |
| Police chief: Stolen vehicle with child inside crashes in Tarrytown; suspects on the loose News 12 Bronx |
 "police" - Google News 16h "police" - Google News 16h |
| Zephyrhills man accused of fighting Capitol police, smashing window on Jan. 6 - Tampa... |
| Zephyrhills man accused of fighting Capitol police, smashing window on Jan. 6 Tampa Bay Times |
 "police" - Google News 16h "police" - Google News 16h |
| Topeka Police make robbery, drug arrest - WIBW |
| Topeka Police make robbery, drug arrest WIBW |
 "police" - Google News 16h "police" - Google News 16h |
 | Jets won't be drafting a quarterback in 2022 NFL Draft |
| As part of The Post's 2022 NFL Draft preview, we examine what the Jets might do at each position. Next... |
 NY Post: NYPD Blotter 17h NY Post: NYPD Blotter 17h |
 | Baltimore firefighter deaths in vacant home ruled homicides |
| The deaths of three Baltimore firefighters who perished after being trapped in a burning vacant row home... |
 NY Post: NYPD Blotter 17h NY Post: NYPD Blotter 17h |
 | Yankees' Aaron Hicks: Vladimir Guerrero Jr.'s first homer wasn't a HR |
| Aaron Hicks nearly robbed Vladimir Guerrero Jr. of his milestone night. The Yankees center fielder wasn't... |
 NY Post: NYPD Blotter 17h NY Post: NYPD Blotter 17h |
 | Bodybuilding champion Cedric McMillan dead at 44: reports |
| Cedric McMillan, a world-class bodybuilder and former U.S. Army instructor at Fort Jackson in South Carolina,... |
 NY Post: NYPD Blotter 17h NY Post: NYPD Blotter 17h |
 | Eric Adams rips BLM, anti-cop activists after night of NYC shootings |
| Three people were killed and at least 13 others were wounded in a series of shootings that rocked parts... |
 NY Post: NYPD Blotter 17h NY Post: NYPD Blotter 17h |
 | Long Island police release new video of Gilgo Beach murder victim |
| Long Island officials publicly ramped up efforts Tuesday to catch the elusive Gilgo Beach serial killer,... |
 NY Post: NYPD Blotter 17h NY Post: NYPD Blotter 17h |
| Old Lycoming Township navigates tensions over handling of police leadership role... |
| Old Lycoming Township navigates tensions over handling of police leadership role Williamsport Sun-Gazette |
 "police" - Google News 17h "police" - Google News 17h |
| Kent police investigate fatal shooting at a cemetery - The Seattle Times |
| Kent police investigate fatal shooting at a cemetery The Seattle Times |
 "police" - Google News 17h "police" - Google News 17h |
| Police: Officer, 2 Others Killed in Gas Station Shooting - U.S. News & World Report |
| Police: Officer, 2 Others Killed in Gas Station Shooting U.S. News & World Report |
 "police" - Google News 17h "police" - Google News 17h |
| Have you seen this man? Police say he disappeared from Kyle on Wednesday - KSAT San... |
| Have you seen this man? Police say he disappeared from Kyle on Wednesday KSAT San Antonio |
 "police" - Google News 17h "police" - Google News 17h |
| Pocatello Police warn of dangerous drugs - Local News 8 - LocalNews8.com |
| Pocatello Police warn of dangerous drugs - Local News 8 LocalNews8.com |
 "police" - Google News 17h "police" - Google News 17h |
| Driver Fleeing Near North Traffic Stop Strikes Officer, 3 Others: Chicago Police... |
| Driver Fleeing Near North Traffic Stop Strikes Officer, 3 Others: Chicago Police NBC Chicago |
 "police" - Google News 17h "police" - Google News 17h |
| Man arrested, accused of killing woman over bowling ball, police say - CBS 46 News |
| Man arrested, accused of killing woman over bowling ball, police say CBS 46 News |
 "police" - Google News 17h "police" - Google News 17h |
| Police investigate allegations of women being drugged at popular North Bay bar -... |
| Police investigate allegations of women being drugged at popular North Bay bar KTVU FOX 2 San Francisco |
 "police" - Google News 18h "police" - Google News 18h |
| Henderson police: Boy shot and killed by 14-year-old brother - News3LV |
| Henderson police: Boy shot and killed by 14-year-old brother News3LV |
 "police" - Google News 18h "police" - Google News 18h |
| Trial continues for Malik Koval, charged with 2018 Falmouth police shooting - Cape... |
| Trial continues for Malik Koval, charged with 2018 Falmouth police shooting Cape Cod Times |
 "police" - Google News 18h "police" - Google News 18h |
| Man's organ donation leads to 'Easter miracle' for retired NYPD officer - 69News... |
| Man's organ donation leads to 'Easter miracle' for retired NYPD officer 69News WFMZ-TV |
 "NYPD" - Google News 18h "NYPD" - Google News 18h |
 | CJ McCollum, Brandon Ingram lead Pelicans to play-in win over Spurs |
| CJ McCollum scored 27 of his 32 points in the first half, Brandon Ingram shook foul trouble to add 27... |
 NY Post: NYPD Blotter 18h NY Post: NYPD Blotter 18h |
 | NYCFC fall to Sounders in CONCACAF Champions League semifinals |
| The Seattle Sounders reached the CONCACAF Champions League final for the first time, beating New York... |
 NY Post: NYPD Blotter 18h NY Post: NYPD Blotter 18h |
 | Hornets' Miles Bridges appears to hit young girl with his mouthpiece after ugly loss |
| This was a frustrating night for the Charlotte Hornets and especially Miles Bridges. |
 NY Post: NYPD Blotter 18h NY Post: NYPD Blotter 18h |
 | Thandiwe Newton axed from 'Magic Mike' sequel after fight with Channing Tatum over... |
| The feud between Thandiwe Newton and Channing Tatum escalated to such "astonishing" and "unimaginably... |
 NY Post: NYPD Blotter 18h NY Post: NYPD Blotter 18h |
 | NJ women's prison inmates pregnant after sex with transgender prisoner |
| Two inmates serving time in New Jersey's only state prison for women became pregnant after they had sex... |
 NY Post: NYPD Blotter 18h NY Post: NYPD Blotter 18h |
 | 14-year-old boy stabbed at NYC subway station in unprovoked attack |
| The teen was attacked by an unknown suspect after he exited a southbound 7 train at the 90 Street-Elmhurst... |
 NY Post: NYPD Blotter 18h NY Post: NYPD Blotter 18h |
 | Jalen Rose pairs up with Iman Shumpert to talk dancing & the NBA |
| When you're a professional athlete, people want to put you in a box. But my "Renaissance Man" guest this... |
 NY Post: NYPD Blotter 18h NY Post: NYPD Blotter 18h |
 | Nets-Celtics stars the same, but teams are very different this time around |
| The teams are technically the same, and so are the top three players — Kevin Durant and Kyrie Irving... |
 NY Post: NYPD Blotter 18h NY Post: NYPD Blotter 18h |
| San Jose police investigating fatal shooting - KRON4 |
| San Jose police investigating fatal shooting KRON4 |
 "police" - Google News 18h "police" - Google News 18h |
| Detroit police, city workers help clear elderly resident's home blight - FOX 2 Detroit |
| Detroit police, city workers help clear elderly resident's home blight FOX 2 Detroit |
 "police" - Google News 18h "police" - Google News 18h |
| Chico police locate 13-year-old runaway - Action News Now |
| Chico police locate 13-year-old runaway Action News Now |
 "police" - Google News 18h "police" - Google News 18h |
| Police: Charges pending against pedestrian after he was struck in Middletown - Hamilton... |
| Police: Charges pending against pedestrian after he was struck in Middletown Hamilton Journal News |
 "police" - Google News 18h "police" - Google News 18h |
| Man who exchanged gunfire with Prichard Police identified - WKRG News 5 |
| Man who exchanged gunfire with Prichard Police identified WKRG News 5 |
 "police" - Google News 18h "police" - Google News 18h |
| Roads Closed As Police Investigation Continues: Guilford Police - Guilford, CT Patch |
| Roads Closed As Police Investigation Continues: Guilford Police Guilford, CT Patch |
 "police" - Google News 18h "police" - Google News 18h |
| Brooklyn subway suspect tipped off police to his location - WSAZ |
| Brooklyn subway suspect tipped off police to his location WSAZView Full Coverage on Google News |
 "police" - Google News 18h "police" - Google News 18h |
| Great Falls Police Department welcomes a new officer - KRTV NEWS Great Falls |
| Great Falls Police Department welcomes a new officer KRTV NEWS Great Falls |
 "police" - Google News 19h "police" - Google News 19h |
| Police make second arrest in string of drive-by shootings in North Champaign - wcia.com |
| Police make second arrest in string of drive-by shootings in North Champaign wcia.com |
 "police" - Google News 19h "police" - Google News 19h |
| Working Wednesdays: Mount Pleasant Police Department hiring officers - Live 5 News... |
| Working Wednesdays: Mount Pleasant Police Department hiring officers Live 5 News WCSC |
 "police" - Google News 19h "police" - Google News 19h |
| Milwaukee police pursuit, crash: 2 seriously injured, 3 arrested - FOX 6 Milwaukee |
| Milwaukee police pursuit, crash: 2 seriously injured, 3 arrested FOX 6 Milwaukee |
 "police" - Google News 19h "police" - Google News 19h |
| Police search for possible robbery suspects inside Northridge mall - CBS News |
| Police search for possible robbery suspects inside Northridge mall CBS News |
 "police" - Google News 19h "police" - Google News 19h |
| Georgia college professor calls police on students who arrived late to class - KWCH |
| Georgia college professor calls police on students who arrived late to class KWCH |
 "police" - Google News 19h "police" - Google News 19h |
| Woman overdoses in Cheesecake Factory restroom: Lyndhurst Police Blotter - cleveland.com |
| Woman overdoses in Cheesecake Factory restroom: Lyndhurst Police Blotter cleveland.com |
 "police" - Google News 19h "police" - Google News 19h |
| Police identify remains of missing 8-year-old boy; nationwide arrest warrant includes... |
| Police identify remains of missing 8-year-old boy; nationwide arrest warrant includes father KY3 |
 "police" - Google News 19h "police" - Google News 19h |
| Clifton Police looking for man who has a 'problem keeping hands to himself' - KWTX |
| Clifton Police looking for man who has a 'problem keeping hands to himself' KWTX |
 "police" - Google News 19h "police" - Google News 19h |
| Car shot several times was case of mistaken ID, Burton police say; suspect in custody... |
| Car shot several times was case of mistaken ID, Burton police say; suspect in custody MLive.com |
 "police" - Google News 19h "police" - Google News 19h |
| Police identify Troutdale armed robbery suspects, 1 remains at large - KOIN.com |
| Police identify Troutdale armed robbery suspects, 1 remains at large KOIN.com |
 "police" - Google News 19h "police" - Google News 19h |
| Police charge Richmond 20-year-old with murder after fatal Southside shooting - WRIC... |
| Police charge Richmond 20-year-old with murder after fatal Southside shooting WRIC ABC 8News |
 "police" - Google News 19h "police" - Google News 19h |
| Next step for town: Appoint police review board members - Bennington Banner |
| Next step for town: Appoint police review board members Bennington Banner |
 "police" - Google News 19h "police" - Google News 19h |
| Albemarle Police: Man dies after 'a gun unintentionally discharged' - The Stanly... |
| Albemarle Police: Man dies after 'a gun unintentionally discharged' - The Stanly News & Press | The... |
 "police" - Google News 19h "police" - Google News 19h |
| Salem police officer investigating stolen vehicle shoots, kills man during fight... |
| Salem police officer investigating stolen vehicle shoots, kills man during fight Statesman Journal |
 "police" - Google News 19h "police" - Google News 19h |
| Twitter hilariously reacts to police pulling over driverless car - CNN |
| Twitter hilariously reacts to police pulling over driverless car CNN |
 "police" - Google News 19h "police" - Google News 19h |
 | Alexis Lafreniere's absence highlights Rangers' looming third-line conundrum |
| PHILADELPHIA — The Rangers found a productive third-line connection between Filip Chytil and Kaapo Kakko... |
 NY Post: NYPD Blotter 20h NY Post: NYPD Blotter 20h |
 | Pete Alonso thriving as Mets' DH but still wants to play first base |
| PHILADELPHIA — The results are not changing Pete Alonso's mind. He wants to play first base, even though... |
 NY Post: NYPD Blotter 20h NY Post: NYPD Blotter 20h |
 | DOE slated to announce plans for NYC's Gifted and Talented program |
| The anticipated announcement comes after former mayor Bill de Blasio tried to nix the program at the... |
 NY Post: NYPD Blotter 20h NY Post: NYPD Blotter 20h |
 | Trae Young leads Hawks to blowout play-in game win over Hornets |
| Trae Young bounced back from a sluggish start to score 24 points and De'Andre Hunter led a third-quarter... |
 NY Post: NYPD Blotter 20h NY Post: NYPD Blotter 20h |
 | Vladimir Guerrero Jr. hits three HRs, Gerrit Cole struggles as Yankees fall |
| The Yankees left Vladimir Guerrero Jr. bloodied, but the Blue Jays' young star inflicted the most serious... |
 NY Post: NYPD Blotter 20h NY Post: NYPD Blotter 20h |
| Police takedown caught on video but left out of official reports - FOX 6 Milwaukee |
| Police takedown caught on video but left out of official reports FOX 6 Milwaukee |
 "police" - Google News 20h "police" - Google News 20h |
| Forks Twp. police searching for another person in distraction thefts at Giant Food... |
| Forks Twp. police searching for another person in distraction thefts at Giant Food Store, Park Plaza... |
 "police" - Google News 20h "police" - Google News 20h |
| MBTA, Boston police boost security ahead of Boston Marathon in wake of NYC subway... |
| MBTA, Boston police boost security ahead of Boston Marathon in wake of NYC subway shooting MassLive.com |
 "police" - Google News 20h "police" - Google News 20h |
| Oakland police need help identifying suspects wanted in separate shootings - KTVU... |
| Oakland police need help identifying suspects wanted in separate shootings KTVU FOX 2 San Francisco |
 "police" - Google News 20h "police" - Google News 20h |
| Three shot outside Brooklyn NYCHA development: NYPD - PIX11 |
| Three shot outside Brooklyn NYCHA development: NYPD PIX11 |
 "NYPD" - Google News 20h "NYPD" - Google News 20h |
| NYPD: Man wanted in Brooklyn subway attack arrested - USA TODAY |
| NYPD: Man wanted in Brooklyn subway attack arrested USA TODAY |
 "NYPD" - Google News 20h "NYPD" - Google News 20h |
| Central Pa. man, 57, sexually abused girl, 8: police - PennLive |
| Central Pa. man, 57, sexually abused girl, 8: police PennLive |
 "police" - Google News 20h "police" - Google News 20h |
| Woman steals decorated skeleton from Texas library, police asking for help identifying... |
| Woman steals decorated skeleton from Texas library, police asking for help identifying her WFAA.com |
 "police" - Google News 20h "police" - Google News 20h |
| How to curb your anxiety before a police oral board interview - Police News |
| How to curb your anxiety before a police oral board interview Police News |
 "police" - Google News 20h "police" - Google News 20h |
| Police: Officer shoots armed man near South Renton Park & Ride - FOX 13 Seattle |
| Police: Officer shoots armed man near South Renton Park & Ride FOX 13 Seattle |
 "police" - Google News 20h "police" - Google News 20h |
| Missing 16-year-old Florence girl found, police say - wpde.com |
| Missing 16-year-old Florence girl found, police say wpde.com |
 "police" - Google News 20h "police" - Google News 20h |
| Quinnen Williams, former Alabama All-American, shows Birmingham police people 'really... |
| Quinnen Williams, former Alabama All-American, shows Birmingham police people 'really love' them AL.com |
 "police" - Google News 20h "police" - Google News 20h |
| CTA and police increased security to combat a spike in transit crime. Will it work?... |
| CTA and police increased security to combat a spike in transit crime. Will it work? Chicago Tribune |
 "police" - Google News 20h "police" - Google News 20h |
| Rantoul Police investigating after man found dead inside house - wcia.com |
| Rantoul Police investigating after man found dead inside house wcia.com |
 "police" - Google News 20h "police" - Google News 20h |
| New Braunfels woman arrested one month after deadly crash in Seguin, police say -... |
| New Braunfels woman arrested one month after deadly crash in Seguin, police say KSAT San Antonio |
 "police" - Google News 21h "police" - Google News 21h |
| Brooklyn subway suspect tipped off police to his location - ABC News |
| Brooklyn subway suspect tipped off police to his location ABC NewsView Full Coverage on Google News |
 "police" - Google News 21h "police" - Google News 21h |
| Thief steals car with toddler inside, hits 100 mph in police chase - FOX 31 Denver |
| Thief steals car with toddler inside, hits 100 mph in police chase FOX 31 Denver |
 "police" - Google News 21h "police" - Google News 21h |
| Police arrest suspect in Barre City shooting - WCAX |
| Police arrest suspect in Barre City shooting WCAX |
 "police" - Google News 21h "police" - Google News 21h |
| Citing police costs, Little Mekong Night Market joins growing list of canceled St.... |
| Citing police costs, Little Mekong Night Market joins growing list of canceled St. Paul street festivals St.... |
 "police" - Google News 21h "police" - Google News 21h |
| Dayton switches police patrol approach, worries about officer shortage - Dayton Daily... |
| Dayton switches police patrol approach, worries about officer shortage Dayton Daily News |
 "police" - Google News 21h "police" - Google News 21h |
| San Jose police seek red pickup driver after 2 women die in hit and run - KTVU FOX... |
| San Jose police seek red pickup driver after 2 women die in hit and run KTVU FOX 2 San Francisco |
 "police" - Google News 21h "police" - Google News 21h |
| Sheriff: Boynton Beach interested in merging its police department with his office... |
| Sheriff: Boynton Beach interested in merging its police department with his office WPEC |
 "police" - Google News 21h "police" - Google News 21h |
| Robot Dogs Join the New York Fire Department - The New York Times |
| Robot Dogs Join the New York Fire Department The New York Times |
 "police" - Google News 21h "police" - Google News 21h |
| What is the NYPD Crime Stoppers hotline? - CNN |
| What is the NYPD Crime Stoppers hotline? CNN |
 "NYPD" - Google News 21h "NYPD" - Google News 21h |
| How the NYPD Located the Brooklyn Shooting Suspect - NBC Chicago |
| How the NYPD Located the Brooklyn Shooting Suspect NBC Chicago |
 "NYPD" - Google News 21h "NYPD" - Google News 21h |
 | 'Game of Thrones' actor arrested for alleged contact with a minor for sexual offense |
| He was arrested by the LAPD after allegedly engaging in sexually explicit online communication with a... |
 NY Post: NYPD Blotter 21h NY Post: NYPD Blotter 21h |
 | Kaapo Kakko's two-goal night leads Rangers to easy win over Flyers |
| Kaapo Kakko scored a pair of goals and Alexandar Georgiev made 28 saves to lead the visiting Rangers... |
 NY Post: NYPD Blotter 21h NY Post: NYPD Blotter 21h |
 | It will be a surprise if Giants take a quarterback in 2022 NFL Draft |
| As part of The Post's 2022 NFL Draft preview, we examine what the Giants might do at each position. Wednesday:... |
 NY Post: NYPD Blotter 21h NY Post: NYPD Blotter 21h |
 | 'Senior citizen' Keith Hernandez says he almost fell for phishing scam |
| SNY color commentator Keith Hernandez humorously revealed to Mets fans during Wednesday's broadcast in... |
 NY Post: NYPD Blotter 21h NY Post: NYPD Blotter 21h |
 | Travis Barker gets hawk tattoo in honor of Taylor Hawkins |
| "HAWK forever 🦅," the Blink-182 drummer captioned a series of photos on Instagram of his ink session... |
 NY Post: NYPD Blotter 21h NY Post: NYPD Blotter 21h |
 | 'Harmony' review: Barry Manilow's musical has flaws, but stellar singing |
| Barry Manilow's new musical "Harmony" has a lot going for it. Still, there is some discord. |
 NY Post: NYPD Blotter 21h NY Post: NYPD Blotter 21h |
 | Reggie Jackson outraged by Dodgers pulling Clayton Kershaw with perfect game |
| Count Mr. October among those outraged that the Dodgers pulled Clayton Kershaw after seven perfect innings... |
 NY Post: NYPD Blotter 21h NY Post: NYPD Blotter 21h |
 | Mets pitching rotation amazin'ly thriving without ailing Jacob deGrom |
| A week into the regular season, the Mets are succeeding even without Jacob deGrom and with Max Scherzer... |
 NY Post: NYPD Blotter 21h NY Post: NYPD Blotter 21h |
| Grant money to help 2 Metro East police departments equip officers with body cameras... |
| Grant money to help 2 Metro East police departments equip officers with body cameras KMOV4 |
 "police" - Google News 21h "police" - Google News 21h |
| Tulsa Police: Shooting Suspect In Custody, 1 Hostage Dead - News On 6 |
| Tulsa Police: Shooting Suspect In Custody, 1 Hostage Dead News On 6 |
 "police" - Google News 21h "police" - Google News 21h |
| Cape Girardeau police investigating report of shots fired - KFVS |
| Cape Girardeau police investigating report of shots fired KFVS |
 "police" - Google News 21h "police" - Google News 21h |
| Springfield Police arrest reckless driver, juvenile carrying firearm - Western Massachusetts... |
| Springfield Police arrest reckless driver, juvenile carrying firearm Western Massachusetts News |
 "police" - Google News 21h "police" - Google News 21h |
| UPDATE: Eastbound I-580 in Livermore Reopens Following Police Investigation - CBS... |
| UPDATE: Eastbound I-580 in Livermore Reopens Following Police Investigation CBS San Francisco |
 "police" - Google News 21h "police" - Google News 21h |
| Seven teenagers arrested in connection with the Lapsus$ hacking group - The Verge |
| Seven teenagers arrested in connection with the Lapsus$ hacking group The Verge |
 "police" - Google News 21h "police" - Google News 21h |
| NYPD: Man wanted in Brooklyn subway attack arrested - ABC10.com KXTV |
| NYPD: Man wanted in Brooklyn subway attack arrested ABC10.com KXTV |
 "NYPD" - Google News 22h "NYPD" - Google News 22h |
| How the NYPD Located the Brooklyn Shooting Suspect - NBC 5 Dallas-Fort Worth |
| How the NYPD Located the Brooklyn Shooting Suspect NBC 5 Dallas-Fort Worth |
 "NYPD" - Google News 22h "NYPD" - Google News 22h |
| Downriver woman says she was struck with frozen Orbeez water pellets: Police say... |
| Downriver woman says she was struck with frozen Orbeez water pellets: Police say dangerous TickTock challenge... |
 "police" - Google News 22h "police" - Google News 22h |
| Billings police investigating new Khoen Parker social media tip as community remains... |
| Billings police investigating new Khoen Parker social media tip as community remains frustrated Q2 News |
 "police" - Google News 22h "police" - Google News 22h |
| University of Florida Police Department under fire after racial discrimination complaint... |
| University of Florida Police Department under fire after racial discrimination complaint Gainesville... |
 "police" - Google News 22h "police" - Google News 22h |
| Renton police shoot man after responding to call of armed subject in crisis - The... |
| Renton police shoot man after responding to call of armed subject in crisis The Seattle Times |
 "police" - Google News 22h "police" - Google News 22h |
| Pasco Police identify human remains as 8-year-old Edgar Casian who went missing in... |
| Pasco Police identify human remains as 8-year-old Edgar Casian who went missing in 2020 NBC Right Now |
 "police" - Google News 22h "police" - Google News 22h |
| Dad accidentally runs over 2-year-old, killing him, police say - WBRC |
| Dad accidentally runs over 2-year-old, killing him, police say WBRC |
 "police" - Google News 22h "police" - Google News 22h |
| Dealership stripes Ferrari to look like West Bloomfield police car - Detroit News |
| Dealership stripes Ferrari to look like West Bloomfield police car Detroit News |
 "police" - Google News 22h "police" - Google News 22h |
| Rochester Police: Man found dead behind vacant house was murdered - 13WHAM-TV |
| Rochester Police: Man found dead behind vacant house was murdered 13WHAM-TV |
 "police" - Google News 22h "police" - Google News 22h |
| NYPD class of 2022 celebrates graduation day - CBS New York |
| NYPD class of 2022 celebrates graduation day CBS New York |
 "NYPD" - Google News 22h "NYPD" - Google News 22h |
| Police investigating after wire tied like noose found near school in Enfield - Eyewitness... |
| Police investigating after wire tied like noose found near school in Enfield Eyewitness News 3 |
 "police" - Google News 22h "police" - Google News 22h |
| Park Police, Secret Service reach settlement over 2020 protests - Roll Call |
| Park Police, Secret Service reach settlement over 2020 protests Roll Call |
 "police" - Google News 22h "police" - Google News 22h |
| 'Positive for transparency': Bend police say officer body cameras have been a success... |
| 'Positive for transparency': Bend police say officer body cameras have been a success KTVZ |
 "police" - Google News 22h "police" - Google News 22h |
| Nursing home employee arrested after assault on a resident, police say - FOX 29 Philadelphia |
| Nursing home employee arrested after assault on a resident, police say FOX 29 Philadelphia |
 "police" - Google News 22h "police" - Google News 22h |
| Alpine closed between 9th, Verdant for Longmont police "operation" - Boulder Daily... |
| Alpine closed between 9th, Verdant for Longmont police "operation" Boulder Daily Camera |
 "police" - Google News 22h "police" - Google News 22h |
| Peoria Police arrest person of interest after shots fired incident - CIProud.com |
| Peoria Police arrest person of interest after shots fired incident CIProud.com |
 "police" - Google News 22h "police" - Google News 22h |
| Moab hires UHP Capt. Jared Garcia as new chief of police - KSL.com |
| Moab hires UHP Capt. Jared Garcia as new chief of police KSL.com |
 "police" - Google News 22h "police" - Google News 22h |
 | Ben Simmons may play for Nets against Celtics after 'heavier progress' |
| Ben Simmons and his bad back are in a race against time, hoping to get on the court before the Nets run... |
 NY Post: NYPD Blotter 23h NY Post: NYPD Blotter 23h |
 | Adams says social media firms should have flagged alleged subway shooter Frank James'... |
| The 62-year-old posted a string of videos on YouTube which frequently included racist diatribes and in... |
 NY Post: NYPD Blotter 23h NY Post: NYPD Blotter 23h |
 | Gov. Hochul's chief of staff pays price for disastrous vetting of Brian Benjamin:... |
| Gov. Kathy Hochul's longtime chief of staff played a key role in her decision to name Brian Benjamin... |
 NY Post: NYPD Blotter 23h NY Post: NYPD Blotter 23h |
 | Yankees' Isiah Kiner-Falefa confident he will overcome slow start |
| Isiah Kiner-Falefa admits to having jitters over his first few games with the Yankees while manning the... |
 NY Post: NYPD Blotter 23h NY Post: NYPD Blotter 23h |
 | Brian Austin Green 'bedridden' for six weeks with ulcerative colitis |
| "Sharna was amazing. Six, seven months pregnant, taking care of my three young kids because I was pretty... |
 NY Post: NYPD Blotter 23h NY Post: NYPD Blotter 23h |
 | Brian Benjamin just the latest in a long line of sleazy New York pols |
| The latest disgraced New York political figure is Lt. Gov. Brian Benjamin, who resigned and surrendered... |
 NY Post: NYPD Blotter 23h NY Post: NYPD Blotter 23h |
 | Yankees' Aaron Hicks: Playing winter ball in Dominican Republic has paid off |
| It was just 12 games, but they were enough to let Aaron Hicks know he was good to go. After losing most... |
 NY Post: NYPD Blotter 23h NY Post: NYPD Blotter 23h |
 | Tom Seaver statue will be bittersweet for ex-Mets teammates: 'Wish he could see it' |
| For the two old southpaws, both now in their 70s, the statue that will soon dominate Citi Field is a... |
 NY Post: NYPD Blotter 23h NY Post: NYPD Blotter 23h |
 | Sherri Papini arraigned in court on kidnapping hoax charges |
| Sherri Papini, who was the mastermind of an elaborate kidnapping scheme, plans to plead guilty to one... |
 NY Post: NYPD Blotter 23h NY Post: NYPD Blotter 23h |
 | Socialists slam 'bloated' NYPD presence in subways as ineffective against crime |
| The Democratic Socialists of America slammed Mayor Eric Adams Wednesday for deploying a "bloated" police... |
 NY Post: NYPD Blotter 23h NY Post: NYPD Blotter 23h |
 | 'The Call' 2013 Movie Ending, Explained |
| We're answering your call for answers! |
 NY Post: NYPD Blotter 23h NY Post: NYPD Blotter 23h |
 | Accused subway shooter Frank James bought smoke bombs, other fireworks in Wisconsin |
| The crazed man accused in the Brooklyn subway shooting had stocked up on smoke bombs at a store miles... |
 NY Post: NYPD Blotter 23h NY Post: NYPD Blotter 23h |
 | Nets' defense against Celtics' Jayson Tatum may determine playoff series |
| The Celtics' Jayson Tatum said he learned a lot watching Kyrie Irving, who was already at the level he... |
 NY Post: NYPD Blotter 23h NY Post: NYPD Blotter 23h |
 | Al Pacino, 81, started dating Noor Alfallah, 28, during the pandemic |
| Pacino and Alfallah, who comes from a wealthy Kuwaiti-American family, were pictured together this week... |
 NY Post: NYPD Blotter 23h NY Post: NYPD Blotter 23h |
 | Joe Rogan, Bill Maher trash medicine, big pharma, vaccines: 'Don't trust them' |
| "Most people are giving us too much credit for where we are medically," said "Real Time" host Maher on... |
 NY Post: NYPD Blotter 23h NY Post: NYPD Blotter 23h |
 | Desmond Ridder's intangibles make him intriguing QB option in 2022 NFL Draft |
| Desmond Ridder Ridder went 44-6 — the third-most wins in FBS history, behind Kellen Moore and Colt McCoy.... |
 NY Post: NYPD Blotter 23h NY Post: NYPD Blotter 23h |
| Owner says dog was fatally shot by Jacksonville police officer - WJXT News4JAX |
| Owner says dog was fatally shot by Jacksonville police officer WJXT News4JAX |
 "police" - Google News 23h "police" - Google News 23h |
| Police drop all charges against man accused of shooting officer, name new suspect... |
| Police drop all charges against man accused of shooting officer, name new suspect WSB Atlanta |
 "police" - Google News 23h "police" - Google News 23h |
| Zulgad: Fun police got it wrong in criticizing how Timberwolves and their fans celebrated... |
| Zulgad: Fun police got it wrong in criticizing how Timberwolves and their fans celebrated victory – SKOR... |
 "police" - Google News 23h "police" - Google News 23h |
| Havelock promotes from within for new police chief - WITN |
| Havelock promotes from within for new police chief WITN |
 "police" - Google News 23h "police" - Google News 23h |
| St. Joseph police looking to identify individuals - ABC 57 News |
| St. Joseph police looking to identify individuals ABC 57 News |
 "police" - Google News 23h "police" - Google News 23h |
| Durham police investigate 2 deadly shootings 1 hour apart - CBS17.com |
| Durham police investigate 2 deadly shootings 1 hour apart CBS17.com |
 "police" - Google News 23h "police" - Google News 23h |
| Idaho Falls police officer 'very relieved' after judge dismisses case against him... |
| Idaho Falls police officer 'very relieved' after judge dismisses case against him East Idaho News |
 "police" - Google News 23h "police" - Google News 23h |
| New Haven police sergeant placed on paid leave - New Haven Register |
| New Haven police sergeant placed on paid leave New Haven Register |
 "police" - Google News 23h "police" - Google News 23h |
| NYPD: Teen grazed in the head outside Atlantic Terminal Mall - News 12 Bronx |
| NYPD: Teen grazed in the head outside Atlantic Terminal Mall News 12 Bronx |
 "NYPD" - Google News 23h "NYPD" - Google News 23h |
| NYPD data shows a crime spike in New York City transit system - News 12 Westchester |
| NYPD data shows a crime spike in New York City transit system News 12 Westchester |
 "NYPD" - Google News 23h "NYPD" - Google News 23h |
| How the NYPD Located the Brooklyn Shooting Suspect - NBC 6 South Florida |
| How the NYPD Located the Brooklyn Shooting Suspect NBC 6 South Florida |
 "NYPD" - Google News 23h "NYPD" - Google News 23h |
| NYPD Arrest NYC Subway Shooting Suspect | Cerritos Community News. - Los Cerritos... |
| NYPD Arrest NYC Subway Shooting Suspect | Cerritos Community News. Los Cerritos News |
 "NYPD" - Google News 23h "NYPD" - Google News 23h |
| NYPD: Suspected gunman in Brooklyn subway attack has ties to Ohio - 10TV |
| NYPD: Suspected gunman in Brooklyn subway attack has ties to Ohio 10TV |
 "NYPD" - Google News 23h "NYPD" - Google News 23h |
| Manchester City's tunnel clash with Atletico Madrid leads to police intervention... |
| Manchester City's tunnel clash with Atletico Madrid leads to police intervention ESPN |
 "police" - Google News 23h "police" - Google News 23h |
| ISP: Wanted Indy man evades police, accepts ride and is driven right back - FOX 59... |
| ISP: Wanted Indy man evades police, accepts ride and is driven right back FOX 59 Indianapolis |
 "police" - Google News 23h "police" - Google News 23h |
| Police detain suspect as operations conclude in Wilder - Vermont Biz |
| Police detain suspect as operations conclude in Wilder Vermont Biz |
 "police" - Google News 23h "police" - Google News 23h |
| Woman eludes police pursuit in stolen North Riverside Mall security vehicle - Riverside... |
| Woman eludes police pursuit in stolen North Riverside Mall security vehicle Riverside Brookfield Landmark |
 "police" - Google News 23h "police" - Google News 23h |
| Man injured, suspect arrested in connection with Union Township shooting, police... |
| Man injured, suspect arrested in connection with Union Township shooting, police say FOX19 |
 "police" - Google News 23h "police" - Google News 23h |
| Activists stand by fired suburban Denver police chief - The Associated Press - en... |
| Activists stand by fired suburban Denver police chief The Associated Press - en Español |
 "police" - Google News 23h "police" - Google News 23h |
Comments
Post a Comment